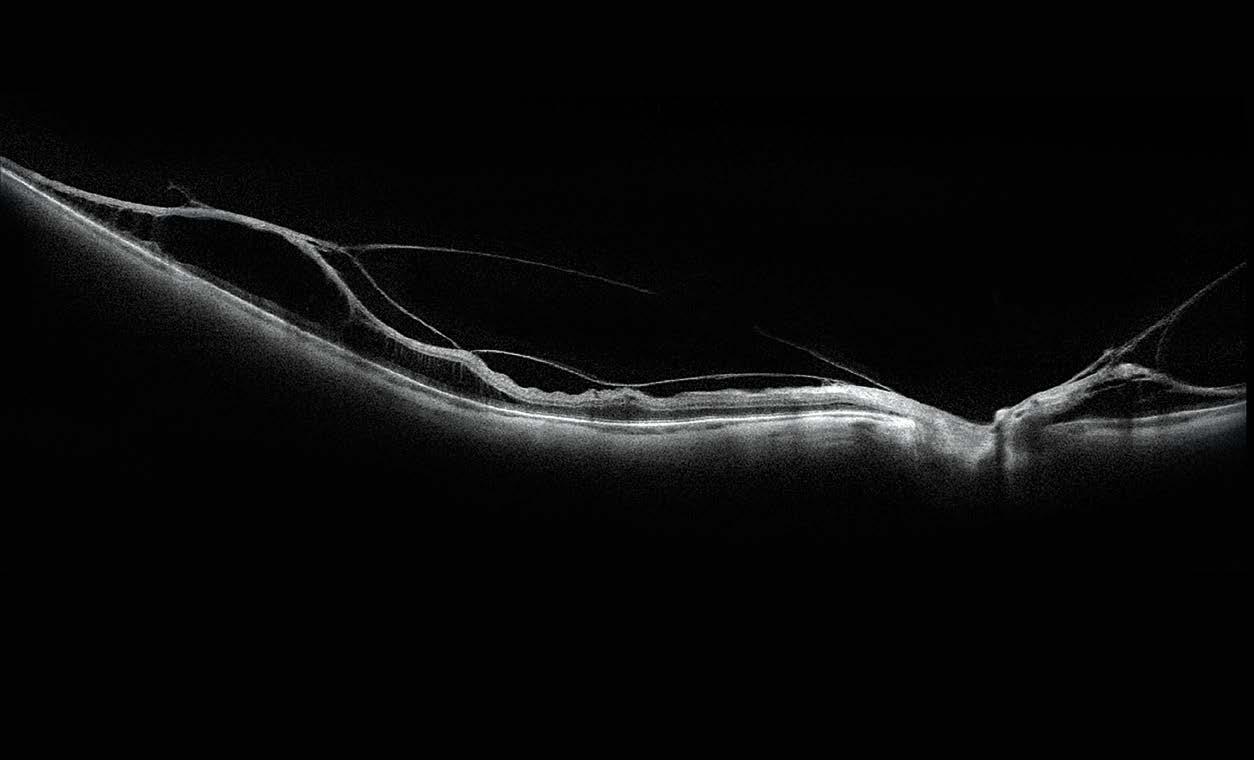

Tratamiento de la retinopatía diabética proliferativa


p.06
Flapectomía como solución al crecimiento intraepitelial por traumatismo en paciente con LASIK previo
p.24
Seguimiento de la progresión del glaucoma: lo probado, lo verdadero y lo nuevo
p.38
Síganos en: /oftalmologoaldia @oftalmologoRO oftalmologoaldia Oftalmólogo Al Día
oftalmologoaldia.com
A
CREATIVE LATIN MEDIA PUBLICATION / SEGUNDA EDICIÓN, ABRIL 2023, VOLUMEN 116


COMITÉ EDITORIAL CLÍNICO
EDITOR CLÍNICO EN JEFE REVIEW OF OPHTHALMOLOGY MÉXICO
Dr. Raúl Suárez Sánchez Asesor del Departamento de Córnea y Cirugía Refractiva Instituto de Oftalmología Conde de Valenciana
COMITÉ EDITORIAL REVIEW OF OPHTHALMOLOGY MÉXICO 2023
Dr. Arturo Ramírez Miranda, Del Conde de Valenciana. Profesor adjunto de oftalmología, médico adscrito del Departamento de Córnea y Cirugía Refractiva del Conde de Valenciana
Dr. Charles Van Lansingh, Director médico Help Me See, director de Investigación del Instituto Mexicano de Oftalmología, presidente del Centro Mexicano de Salud Visual Preventiva y Profesor Asociado del Departamento de Salud Pública, de la Universidad de Miami
Dr. Juan Carlos Serna Ojeda, Presidente de la Asociación Mexicana de Bancos de Tejidos Oculares y presidente del Instituto Visión Láser.
Dra. María Ana Martínez-Castellanos, Cirujano de retina pediátrica
Dra. Silvia Moguel Ancheita, Presidente Sociedad Mexicana de Oftalmología (SMO)
Dr. Jorge E. Valdez-García MD, PhD, Decano de la Escuela de Medicina y Ciencias de la Salud del Tecnológico de Monterrey

Dr. Raúl Suárez Sánchez
Asesor del Departamento de Córnea y Cirugía Refractiva Instituto de Oftalmología Conde de Valenciana
Apreciados colegas:
Estamos entrando en el segundo trimestre del año y le comenté a mis colegas que no creo que la pandemia haya dejado nada bueno, simplemente aceleró los tiempos para el uso de las tecnologías remotas y a distancia.
En el artículo: “Seguimiento de la progresión del glaucoma: lo probado, lo verdadero y lo nuevo”, de Christine Yue L, se comentan y analizan las pruebas remotas, así como la utilidad de la realidad virtual para minimizar los artefactos y mejorar la confiabilidad de las pruebas. Aún y cuando esta tecnología no está totalmente desarrollada para sustituir a las pruebas convencionales, considero que debemos conocerla a fondo.
La retinopatía diabética sigue siendo una de las cinco principales causas de ceguera en adultos estadounidenses de 20 a 74 años, y México está con esta misma tendencia. En el artículo: “Tratamiento de la retinopatía diabética proliferativa”, de Liz Hunter, se comenta que la detección oportuna y el seguimiento adecuado sigue siendo la clave del éxito en el pronóstico visual de estos pacientes.
La Dra. Clemencia de Vivero A. y colaboradores nos envía un interesante caso clínico: “Abordaje de cierre angular agudo” en un paciente con glaucoma agudo.
El artículo “Flapectomía como solución al crecimiento intraepitelial por traumatismo en paciente con LASIK previo”, de la Dra. Valentina Rodríguez M. y colaboradores, presenta el caso de un paciente con una complicación poco frecuente en pacientes operados de Lasik y la forma de resolverlo.
El consejo editorial de Review Of Ophthalmology México en Español invita a nuestros lectores a escribir al correo lmalkinstuart@clatinmedia.com y eolguin@clatinmedia.com sus casos clínicos o experiencias científicas que consideren de interés para compartir con nosotros. Por favor indicarnos, lugar de contacto, número telefónico y correo electrónico.
La Dra. Luisa Anaya y colaboradores nos manda un artículo que a su vez es una recopilación de los mejores artículos sobre diferentes temas de interés: “Los mejores papers del tercer cuatrimestre del 2022”.
Edición no° 2. Volumen 116
2 Review of Ophthalmology México 2023
Carta Editorial
Elizabeth Olguín
Editora en jefe Review of Ophthalmology México eolguin@clatinmedia.com

Bienvenidos a la segunda edición de la revista Review of Ophthalmology México, que este año se viste de gala por su vigésimo aniversario. Durante estas dos décadas la revista ha tenido el privilegio de publicar artículos científicos, casos clínicos, eventos y lo más reciente de la industria. Esta información ha ayudado a actualizar e informar a los médicos oftalmólogos del país.
Actualmente, la revista se distribuye de manera impresa, por medio de la página web oftalmólogoaldia.com y, ahora, por la web app, tres formatos que permiten que la publicación esté en la palma de la mano de los profesionales de la salud visual.
Nuestra web app es el reflejo de una actualización constante y su formato se adapta a todos los dispositivos móviles. Su estructura está diseñada para brindarles una experiencia más interactiva y cuenta con la sección de Oftalmo TV, que contiene tertulias y cápsulas informativas, a través de la sección de sesenta segundos.
ATENEA, el portal de conocimiento oftalmológico, patrocinó, el 1 de abril, la Master Class en vivo: “Manejo de opciones en el tratamiento de la presbicia”, moderada por el Dr. Van C. Lansingh, director médico de ATENEA. La clase tuvo como panelistas a los doctores: Eduardo Viteri, consultor médico y editor Médico de Review of Ophthalmology en Español; Giovanna Benozzi, miembro fundadora de la Sociedad Argentina de Presbicia y directora médica del Centro de Investigación Avanzada de la Presbicia y Rafael Iribarren, investigador en el área de los errores refractivos, especialmente en la miopía, la hipermetropía y la presbicia.
Dentro de la clase, el Dr. Jorge Alió Sanz desarrolló el tema: “Opciones en los Lentes EDOF para la presbicia psedofáquica. Cómo elegirlas y qué ofrecen” y el Dr. Guillermo Ocampo ofreció el tema: “Abordajes quirúrgicos para tratar la presbicia”.
Si no tuvo oportunidad de disfrutar de esta clase puede verla en la página: www.ateneavision.com
Edición no° 2. Volumen
116
Review of Ophthalmology México 2023
Carta Editorial 3
Editora en Jefe: Laura Malkin-Stuart
Editor Clínico en Jefe (En Español): Dr. Eduardo Viteri
Editores (En Español): Juan Pablo Chajin
Editor Clínico en Jefe (México): Dr. Raúl Suárez
Editora en jefe (México): Elizabeth Olguín
Editor Brasil / Universo Visual: Dr. Marcos Ávila
Jefe de Producción: Alejandro Bernal
Diseñadores Gráficos: Nathalia A. López / Ximena Jurado
Ilustración Portada: Walter Muñoz
Ilustración basada en el artículo: Tratamiento de la retinopatía diabética proliferativa
Profesional Logística: Ximena Ortega Bernal
Diseñador Gráfico Medios Digitales: Cristian Puentes G.
Fotógrafo de eventos: Jacobo Plotnicoff
Producida / Editada / Diseñada / Distribuida por: 3 Touch Media S.A.S.
ARTÍCULO
06 Tratamiento de la retinopatía diabética proliferativa Liz Hunter, editora sénior
OFICINAS Y VENTAS
Director Ejecutivo (CEO): Juan Carlos Plotnicoff
Director de Operaciones (COO): Sergio Plotnicoff
Director Comercial: Hector Serna
Directora de Comunicaciones: Laura Malkin-Stuart
Directora de comunicaciones (óptica): Claudia Castillo
Directora Administrativa y financiera: Luisa Fda. Vargas
Creative Latin Media LLC
2901 Clint Moore Rd, P.M.B 117 Boca Raton, FL 33496 USA
Tel: +1 (561) 716 2711
e-mail: suscripciones@clatinmedia.com
Las traducciones y el contenido editorial de Review of Ophthalmology En Español, no pueden ser reproducidos sin el permiso de Creative Latin Media™.
VENTAS
México: Carlos Cerezo, Cel: +52 (1) 5611748192, ccerezo@clatinmedia.com

Andina y Centroam◙érica: Kelly Triana, Cel: +57 320 9454400, ktriana@clatinmedia.com
USA, Europa y Brasil: María Andrea Ortíz, Cel: +57 (320) 945-4390, mortiz@clatinmedia.com, ventas1@clatinmedia.com
Proyectos Especiales: María José Pabón, Cel: +57 (320) 945-4382, mpabon@clatinmedia.com
OFICINAS
USA: 2901 Clint Moore Rd, P.M.B 117
Boca Raton, FL 33496, Tel: +1 (561) 716 271
Colombia: Carrera 7 No. 106 - 73 Of. 301
Bogotá, Colombia, Tel: +57 (310) 304-8820
México: Río Mississippi 49, piso 14, int. 1402. Colonia Cuauhtémoc, Alcaldía Cuauhtémoc, Ciudad de México, CP. 06500, Tel: 5552084148.
Review of Ophthalmology (ISSN 1088-9507) es una revista publicada por Creative Latin Media, LLC bajo licencia de Jobson Publishing LLC. Su distribución es gratuita a todos los profesionales de la Salud Visual que cumplan con los requisitos requeridos para recibir la revista en América Latina.

Tarifas de suscripción anual, seis ediciones. Colombia US$60, México US$60, Latinoamérica (paises de habla hispana) US$120, Brasil US$180, USA y Canada US$220, Europa y Asia US$260. Para suscripciones comuniquese a suscripciones@clatinmedia.com
Otros productos de Creative Latin Media son: 20/20 Andina y Centroamérica, 20/20 México y 20/20 Cono Sur.
14 Los mejores papers del tercer cuatrimestre del 2022 Doctoras:LuisaAnayayAnaS.Serrano
CASOS CLÍNICOS
22 Abordaje de cierre angular agudo Doctoras:ClemenciaDeViveroArciniegasy María Camila González Nieto
ASOCIACIONES Y CONGRESOS
24 Flapectomía como solución al crecimiento intraepitelial por traumatismo en paciente con LASIK previo Doctores:ValentinaRodríguezMartini,JuliaÁlvarez,Rogelio RibesEscuderoyFernandoMayorgaArgañaraz
SECCIONES PATROCINADAS
28 Essilor Luxottica- Un universo de oportunidades para desacelerar la progresión de la miopía en México
PRODUCTOS
34 Dewimed- Reichert 7CR tonómetro automático Tecnología de respuesta corneal
36 OCULUS marca una nueva era en la cirugía del glaucoma
OFTALMÓLOGO DIGITAL
38 Seguimiento de la progresión del glaucoma: lo aprobado, lo verdadero y lo nuevo ChristineYue Leonard, editora séniorasociada
DIRECTORIO
Edición no° 2. Volumen 116 Review of Ophthalmology México 2023 A CREATIVE LATIN MEDIA PUBLICATION / SEGUNDA EDICIÓN, ABRIL 2023, VOLUMEN 116
4

Tratamiento de la retinopatía diabética proliferativa

(Este artículo fue traducido, adaptado e impreso con autorización exclusiva del grupo de revistas de Review de Jobson Medical Information. Su reproducción está prohibida).
Por Liz Hunter, editora sénior
Ya sea con anti-VEGF o PCPR, los resultados de los pacientes pueden depender de su acceso a la atención y la capacidad de seguimiento.
El manejo de pacientes con retinopatía diabética puede ser un desafío. No solo algunos pacientes permanecen asintomáticos y sin darse cuenta del avance de la enfermedad, sino que muchos ni siquiera se someten a exámenes oculares regulares. La retinopatía diabética es la causa número uno de ceguera en adultos estadounidenses de 20 a 74 años, y aunque se recomienda que los diabéticos se hagan exámenes oculares anuales, más del 50% de las personas con RD no reciben las pruebas de detección necesarias.1
Comprender esta población de pacientes es parte integral del tratamiento de su enfermedad, y eso incluye comorbilidades y factores de riesgo que podrían contribuir para su resultado. Hablamos con varios especialistas en retina sobre sus estándares de atención para retinopatía diabética proliferativa específicamente, cómo determinan si un paciente es el más adecuado para la fotocoagulación anti-VEGF o panretiniana y qué sugieren para mejorar la confianza del paciente y el seguimiento.
Figura 1. Imágenes de un paciente varón de unos 30 años con diabetes tipo 2 mal controlada (hemoglobina A1c >12%) y sin atención ocular previa. La angiografía con fluoresceína en la cita inicial mostró áreas extensas de ausencia de perfusión periférica con frondas de neovascularización (se muestra el ojo izquierdo). La OCT mostró edema macular diabético grave que afecta al centro (arriba, a la derecha) que respondió bien a las inyecciones intravítreas de anti-VEGF (aflibercept) (abajo, a la derecha). Un año después de la presentación, tenía 20/20 en ambos ojos con una A1c <7% debido a una mejor adhesión al cuidado de la diabetes y un mejor control sistémico de la glucosa. Foto. Ian C. Han, MD.

Review of Ophthalmology 6 Edición no° 2. Volumen 116 Review of Ophthalmology México 2023
Síntomas de la PRD y cribado
La retinopatía diabética proliferativa (PRD, sigla en inglés) se distingue de la retinopatía diabética no proliferativa en su gravedad. El signo revelador de la PDR es la neovascularización provocada por el control glucémico deficiente, la presión arterial alta, el colesterol alto y otros problemas de salud crónicos. Cuando no se trata, el riesgo de desprendimiento de retina aumenta.

El daño vascular suele ocurrir más en las áreas periféricas de la retina, dice Jason Hsu, MD, codirector de investigación de la retina en Wills Eye Hospital, profesor asistente de oftalmología clínica en el Hospital Universitario Thomas Jefferson, en Filadelfia, y socio gerente de Mid Atlantic Retina.
“Este tipo de paciente puede acudir a su oftalmólogo con pocos o ningún síntoma o, tal vez, solo por un par de gafas y, de paso, descubre que tiene una neovascularización masiva. Su oftalmólogo puede decirle: ‘¡Guau, tiene mucho daño!’ o ’¡Tiene un alto riesgo de perder su visión!’. Y no es raro que no le crea al médico porque su visión sigue siendo bastante buena “, dice. Si se presenta con síntomas, puede incluir la aparición de moscas volantes por alguna hemorragia vítrea. Esos son escenarios muy comunes sobre cómo se diagnostica, por primera vez, a esos pacientes. Otra cosa que puede ocurrirle a todos los diabéticos que tienen retinopatía diabética proliferativa o no proliferativa es el edema macular diabético, y eso causaría un poco más de desenfoque central y también podría ser más sintomático”.
El diagnóstico de pacientes asintomáticos puede tomar un examen cuidadoso, aconseja Ian C. Han, MD, profesor asociado en el departamento de oftalmología y ciencias visuales, en University of Iowa Hospital and Clinics.
“Para mí, la detección todavía comienza con escuchar al paciente y obtener un historial cuidadoso”, dice el Dr. Han. “Por ejemplo, si alguien que acaba de venir para un nuevo examen de la vista, pero ha tenido un diagnóstico de diabetes durante 15 años, su examen inicial ya está alerta a la fuerte posibilidad de PDR. A menudo les digo a los residentes y fellows que asuman por defecto que el paciente tiene PDR, y que se demuestren a sí mismos en el examen clínico que no la tiene; de lo contrario, es posible que no detecten los signos de la enfermedad”.
Diferentes modalidades de imagenología incluyen fotografía basal de fondo de ojo y OCT, así como angiografía con fluoresceína y angiografía con OCT. “La PDR es un poco complicada porque en una OCT es posible que no veamos mucho”, dice el Dr. Hsu.
El Dr. Han está de acuerdo. “Los pacientes con PDR en realidad tienen un fondo de ojo bastante suave; es posible que no veamos una tonelada de hemorragias y demás. En una clínica ocular de rutina podemos ver a un paciente que tiene diabetes mal controlada por 15-20 años y ver una hemorragia puntual aquí o allá asumiéndonos que solo tiene una enfermedad mínima porque la sangre es el hallazgo de fondo de ojo más aparente; sin embargo, de hecho, es una PDR con neovascularización que se pierde”, dice.
Foto. Jennifer I. Lim, MD.
7 Edición no° 2. Volumen 116 Review of Ophthalmology México 2023
Review of Ophthalmology
Figura 2. Este paciente presentó PDR en ambos ojos, lo que se muestra en las imágenes del fondo de ojo preoperatoria tomadas en abril de 2017 (columna de la izquierda). Después del tratamiento con anti-VEGF, la PDR ya no aparece en las imágenes del fondo de ojo un mes después (columna de la derecha).
“Ahora, si se obtiene una OCT de campo más amplio, a veces se puede detectar neovascularización a lo largo de algunas de las arcadas y sobre el nervio óptico”, dice el Dr. Hsu. La neovascularización, a menudo, forma membranas hiperreflectivas, casi como una membrana epirretiniana, pero a veces con una mayor separación por encima del plano de la retina o el nervio óptico. Una cosa a la que es útil prestar atención es la imagen del infrarrojo cercano de la mácula que se utiliza para correlacionar dónde está pasando el corte de la OCT. La neovascularización en la imagen infrarroja cercana, generalmente, se ve oscura y oscurece parte de las arcadas vasculares o el nervio óptico. Si bien eso no es una prueba al 100% de que se trata de neovascularización, puede darle una pista y decirle que lo mire con más cuidado”.
“Con la isquemia y la remodelación vascular, las hemorragias intrarretinianas pueden ser menos prominentes, por lo que los oftalmólogos pueden pasar por alto algunos de los hallazgos más graves o más avanzados que entran en la categoría de la PDR, a menos que estudien los vasos sanguíneos de la retina cuidadosamente en el examen o la imagen”, dice el Dr. Han, con la recomendación de no confiar demasiado en la tecnología para hacer el diagnóstico. “El contexto clínico sigue siendo muy importante. Incluso con la tecnología moderna, algunas anomalías vasculares sutiles pueden no ser tan evidentes, a menos que vaya a buscarlas o estén por debajo de la resolución o la calidad de su imagen”, dice.
Toma de decisiones y discusiones sobre el tratamiento
El tratamiento de la PDR depende de su gravedad. “El láser es la terapia ‘tradicional’ que ha existido durante décadas”, dice el Dr. Hsu. “En este caso, hacemos fotocoagulación panretiniana. Creamos un patrón de láser que está espaciado por aproximadamente un ancho de punto y, generalmente, se mantiene al menos a 1 o 2 diámetros de disco de las arcadas principales y el nervio óptico para no interferir tanto con la percepción del paciente de su visión periférica.” Un estudio del año 1976 fue el primero en mostrar los beneficios de la PCPR para reducir el riesgo de hemorragia vítrea y reducir el riesgo de pérdida de visión en un 50%.2
“Definitivamente, trato de comenzar con la PCPR cuando puedo. Sin embargo, el problema es que, al estar en una práctica de remisión de retina, los pacientes ingresan porque tienen hemorragia vítrea, y en este caso el láser no es efectivo porque la sangre en el vítreo dispersa el rayo láser. Por ello, no se logra obtener una buena absorción”, dice el Dr. Hsu. “En las primeras etapas, el tratamiento es un poco más un juicio clínico, dependiendo de si sentimos que el pa-


ciente mantendrá un seguimiento regular. A veces vemos a personas con alguna neovascularización periférica, pero sin hemorragia vítrea ni síntomas. No tenemos que tratar esos ojos de acuerdo con los estudios porque aún podemos tener buenos resultados si esperamos y solo los tratamos cuando se desarrollen características de alto riesgo”.
Figura 3. Estas imágenes son de una paciente de unos 30 años de edad con diabetes tipo 1 mal controlada. Debido a los determinantes sociales de salud (p. ej.: transporte limitado) no tenía atención ocular previa y su ojo derecho quedó ciego debido al glaucoma neovascular. Se presentó cuando el ojo izquierdo, con mejor visión, no logró contar la agudeza visual de los dedos debido a una hemorragia subhialoidea y desprendimiento de retina por tracción con neovascularización extensa y de aspecto maduro del disco y en otros lugares (a la izquierda). Después de una vitrectomía rápida con extracción de la membrana y colocación con láser, recuperó una agudeza visual de 20/25 (a la derecha) que ha mantenido durante años de seguimiento posterior.
Foto. Ian C. Han, MD.
Hay efectos secundarios bien conocidos a tener en cuenta con la PCPR, incluida la disminución de la sensibilidad al contraste3, la pérdida de la agudeza visual y la constricción del campo visual periférico.4
“Una de las desventajas del láser que discuto con los pacientes es que puede disminuir la visión periférica e incluso la visión nocturna”, dice el Dr. Hsu. “Eso ha sido bien
8 Edición no° 2. Volumen 116 Review of Ophthalmology México 2023
Review of Ophthalmology
Nuevas reglas del juego para la cirugía oftalmológica



Pentacam ® AXL Wave


Esencial en la práctica refractiva durante 20 años
Gracias al flujo de trabajo de medición optimizado y las pantallas resumen orientadas a la aplicación, mejorará aún más la eficiencia de su tiempo. Además, con infinidad de estudios y una gran comunidad de usuarios para respaldar la validez de los datos, que le aportarán la seguridad que busca. Los flujos de trabajo optimizados, los pacientes satisfechos y los mejores resultados clínicos posibles, se logran de forma rápida y fiable y con cortos períodos de formación.




Sin riesgos, solo diversión – Pentacam® AXL Wave
Clic aquí para saber más
ES HORA DE CAMBIAR
!
demostrado porque, esencialmente, se está sacrificando la retina periférica para salvar la retina central. Pero curiosamente, diría que es muy raro que los pacientes se quejen de que perdieron la visión periférica después del láser, porque gran parte de su retina periférica ya es bastante isquémica y, para empezar, no funciona demasiado bien. Tampoco estoy usando una PCPR superpesada, como lo que se pudo haber hecho hace décadas antes de que el anti-VEGF estuviera disponible. Todavía tengo a algunos pacientes a los que se les hizo láser hace 30 o 40 años que están muy bien, con una visión 20/20, pero el láser llega hasta justo afuera de las arcadas. Supongo que tienen un campo de visión mucho más pequeño; sin embargo, no se quejan de ello porque todavía están viendo bien”.

La otra opción de tratamiento es la terapia anti-VEGF. “Anti-VEGF bloquea la vía principal que está llevando al crecimiento neovascular que vemos en la PDR, y eso es bastante sorprendente”, dice el Dr. Hsu. “Por ejemplo, si usted le pone una inyección de un agente anti-VEGF y trae al paciente de vuelta unas horas más tarde o al día siguiente, los vasos a menudo simplemente se derriten muy rápido en respuesta. También es genial que no sea tan destructiva como la PCPR”.
“Cuando empecé en oftalmología, la anti-VEGF era todavía bastante nueva en la práctica clínica rutinaria, y no esperábamos que los pacientes ‘cambiaran el sentido de las cosas’ en términos de la progresión de la enfermedad a la PDR. Todo lo que esperábamos era detener la progresión de la enfermedad “, dice el Dr. Han. “La indicación inicial para la terapia anti-VEGF no era para PDR, sino para edema macular diabético. Por ejemplo, los ensayos clínicos RISE and RIDE con ranibizumab investigaron el efecto de la terapia anti-VEGF en DME, pero sorprendentemente también revirtió la gravedad de la retinopatía diabética para la mayoría de los pacientes. Ahora, la terapia anti-VEGF tiene un sólido historial de funcionar bien y ser eficaz, con la literatura para apoyar múltiples agentes anti-VEGF (bevacizumab [Avastin], ranibizumab [Lucentis], aflibercept [Eylea], etc.) con nuevos medicamentos disponibles (faricimab [Vabysmo]).
El estudio CLARITY, publicado en 2017, comparó el cambio de letra de agudeza visual mejor corregida de un año con los resultados iniciales de los pacientes con PDR tratados con el anti-VEGF aflibercept frente a la PCPR.5 A las 52 semanas, el resultado mostró que aflibercept no era inferior, sino superior a la PCPR (diferencia de agudeza visual media mejor corregida 3,9 letras [IC del 95%: 2,35,6], p<0,0001). Este dato respaldó los hallazgos anteriores del ensayo Protocol S, de la Diabetic Retinopathy Clinical Research Network, de 2015, que mostró que el tratamiento con ranibizumab resultó en una agudeza visual que no era inferior a la PCPR tras evaluarla a lo largo de dos años.6
“Este fue un estudio histórico que realmente condujo al cambio de paradigma de hacer anti-VEGF sobre PCPR,
porque muestra resultados equivalentes con la terapia anti-VEGF en comparación con PCPR”, dice el Dr. Hsu.
“En los últimos años, el tratamiento para PDR se ha dirigido hacia las inyecciones - ciertamente si hay DME -; también, encontrará un amplia variedad de patrones de práctica para PDR sin DME o solo con complicaciones neovasculares”, dice el Dr. Han. “Creo que eso tiene que ver con lo que uno cree que es el tratamiento más efectivo para el grado o la gravedad de la neovascularización existente. La PDR de ‘alto riesgo’ se definió hace décadas (en el Estudio de Retinopatía Diabética) antes de la terapia anti-VEGF o la cirugía de vitrectomía moderna. Hoy en día, creo que un paciente es de ‘alto riesgo’ basado en determinantes sociales de salud que lo afectan, como si el paciente puede seguir un régimen de tratamiento o aspectos de su enfermedad que pueden causar la pérdida irreversible de la visión, como la tracción que conduce al desprendimiento de retina o el glaucoma neovascular”.
capilar.
El hecho de que el anti-VEGF funcione tan bien puede ser en detrimento del paciente, añade el Dr. Hsu. “A veces funciona tan bien que el paciente puede pensar: “¡Me ha curado, no necesito volver!” Y verá muy bien, hasta que la próxima hemorragia o algo más le suceda”, dice.
Este es el quid de un debate en curso entre los especialistas en retina. Tanto anti-VEGF como PCPR requieren un seguimiento regular, y teniendo en cuenta la falta de durabilidad de la anti-VEGF, algunos en el campo argumentan que no es lo suficientemente fuerte como tratamiento en solitario.
“Vemos discusiones en las reuniones, en las que hay un ida y vuelta sobre qué tratamiento es mejor; pero, estoy de acuerdo en que el Santo Grial sería llegar a un tratamiento no destructivo”, dice el Dr. Hsu. “Algunos se han aferrado a la anti-VEGF como el tratamiento no destructivo porque la idea es que, como especialistas
10 Edición no° 2. Volumen 116 Review of Ophthalmology México 2023
Review of Ophthalmology
Figura 4. Imagen de angiografía con fluoresceína de campo amplio del ojo derecho de un paciente con retinopatía diabética proliferativa, que muestra áreas hiperfluorescentes de tinción vascular y fuga junto con áreas hipofluorescentes de no perfusión
Foto. Jason Hsu, MD.
en retina, queremos preservar el funcionamiento de la retina y no destruirla. Y el concepto de sacrificar la retina periférica para salvar la retina central no es necesariamente atractivo para muchas personas.
“Pero, creo que por otro lado todavía no hemos llegado allí”, continúa el Dr. Hsu. “La era anti-VEGF está aquí, pero la entrega de la misma no es ideal para estos pacientes. Mirando hacia atrás en el Protocolo S, pasaron cinco años en ello y encontraron que con la inyección anti-VEGF los pacientes todavía necesitaban un promedio de tres inyecciones al año. Por lo tanto, no es como si hubiera una cura a largo plazo con la terapia continua anti-VEGF; por lo que sabemos, deben seguir recibiéndola indefinidamente. Si hubiera un tratamiento único que proporcionara un bloqueo anti-VEGF a largo plazo, tal vez este sería el Santo Grial y sería lo suficiente para alejar la aguja del láser, en mi mente. Pero personalmente, creo que aún no estamos allí porque hay demasiado en juego para que estos pacientes no se hagan PCPR”.
También hay algunos beneficios de combinar tratamientos. Una revisión colectiva de estudios del año 2022 que evaluó el impacto de la PCPR y el anti-VEGF para la retinopatía diabética encontró nueve ensayos que muestran que una terapia combinada tiene un mejor impacto en mejorar o retrasar el deterioro de la visión en la AVMC, en comparación con la monoterapia, además de mejorar la regresión de la neovascularización sin aumento potencial de la incidencia de eventos adversos.8
“Mi mensaje para los especialistas que administran inyecciones anti-VEGF es que es fundamental continuar realizando PCPR en los ojos con PDR”, dice el Dr. Hsu. “Me doy cuenta de que nuestras prácticas ahora se basan en inyecciones, y arrojan una llave en el flujo del paciente al arrojar el láser. La PCPR lleva más tiempo; sin embargo, no deberíamos sacrificar el láser porque es inconveniente”.
Antes de comenzar cualquier tratamiento, los especialistas en retina tienen que preguntarse: ¿Qué tan probable es que este paciente continúe con el tratamiento?
“El riesgo de pérdida de seguimiento es enorme”, dice Jennifer I. Lim, MD, Marion H. Schenk Esq., cátedra de oftalmología para la investigación en el ojo envejecido, profesora distinguida de oftalmología de la Universidad de Illinois, en Chicago, vicepresidenta de diversidad e inclusión, y directora del servicio de retina en UIC. “Si a un paciente se le administra anti-VEGF y no se realiza un seguimiento, la desventaja es mucho peor que si se le administrara PCPR. Si tiene una inyección anti-VEGF y no vuelve a aparecer, no tengo idea: ¿funcionó?, ¿regresó en un mes, tres meses? Y
entonces esos pacientes no son el tipo que me gustaría ponerles una anti-VEGF”.
Ella dice que algunos factores de riesgo de perder a pacientes durante el seguimiento incluyen el hecho de ser más joven en edad, trabajar en sitios que no permiten tomarse un tiempo libre para las citas, si tienen que viajar largas distancias para recibir atención, así como su estado socioeconómico y raza.
El Dr. Hsu estudió este tema7 e identificó tres factores de riesgo clave de la pérdida de seguimiento (loss to follow-up, LTFU): tipo de procedimiento, edad y raza. “LTFU es un problema más grande de lo que pensábamos”, dice. “Nuestro investigador, Anthony Obeid y yo publicamos, por primera vez un artículo sobre el asunto en 2018. Estábamos mirando nuestra propia práctica y nos centramos en pacientes de alto riesgo con PDR que se habían puesto inyecciones o la PCPR. La pregunta que nos hicimos fue: cuando a un paciente se le pone una inyección anti-VEGF o PCPR, ¿cuántos de ellos no regresan por al menos un año o más inmediatamente después de ese tratamiento?
Descubrimos que alrededor de una cuarta parte de estos pacientes en nuestra práctica se perdieron durante el seguimiento y es posible que no regresen durante un año o más, si es que lo harán alguna vez.
“Es realmente revelador y aterrador”, añade el Dr. Hsu. “En nuestro estudio, algunos de los factores de riesgo de pérdida del seguimiento parecían ser la edad más joven y ser afroamericano o hispano. También realizamos un análisis del código postal de donde viven los pacientes y observamos el ingreso bruto ajustado promedio en ese código postal para tener una idea del nivel de ingresos. Los pacientes que vivían en áreas con ingresos más bajos tenían un mayor riesgo de pérdida del seguimiento”.
Esto provocó otro estudio que evaluó los resultados de los ojos considerados LTFU durante más de seis meses después del procedimiento. La AV empeoró significativamente en ambos grupos, 20/187 para anti-VEGF y 20/83 para PCPR; sin embargo, el grupo PCPR volvió a la línea de base después de la terapia adicional. Ya el grupo anti-VEGF no logró tanta mejora en 20/166.9 Los autores también descubrieron que el 17% de los ojos en el grupo anti-VEGF desarrollaron un desprendimiento de retina traccional (DRT) en la cita de regreso, lo que aumentó al 30% en la visita final. En el grupo PCPR, ningún ojo tenía DRT en la cita de regreso y solo el 2% tenía DRT en la cita final.9
Por esta razón, algunos incluso pueden considerar la PCPR en primer lugar. “Con anti-VEGF, nunca me siento cómodo diciéndome: ‘Está bien, puedo volver a verle en un año’ ”, dice el Dr. Lim. “He tenido a pacientes que estaban muy motivados a regresar para su tratamiento, pero a veces lo interrumpían. Por eso últimamente he estado pensando que sería más fácil para el paciente - y para mí, de alguna manera - simplemente hacerle la PCPR; creo que
Ophthalmology 11 Edición no° 2. Volumen 116 Review of Ophthalmology México 2023
Review of
es una solución más permanente. Y así nos preocupamos menos por la pérdida del seguimiento porque hay algunas cosas fuera del control del paciente”.
El Dr. Hsu dice que no hay una fórmula para predecir quién se perderá en el seguimiento. “Muchos pueden pensar que pueden predecir quién hará el seguimiento observando ciertas características del paciente”, dice. “Desafortunadamente, no sabemos cuándo alguien puede perder su trabajo, tener una enfermedad u otro problema que le impedirá regresar. Aun así, tenemos que fomentar el seguimiento y monitorear a estos pacientes. Realmente vale la pena tener a alguien en su personal que monitoree a cada paciente que recibe una inyección o láser. Si no van a volver, moléstenlos como locos con llamadas telefónicas, cartas certificadas, lo que sea necesario. Estamos enviando un estudio que pronto mostrará nuestros resultados después de contratar a una persona a tiempo completo cuyo trabajo principal es hacer precisamente eso. Si bien descubrimos que marcaba la diferencia, todavía no era el 100%”.
Construyendo la confianza del paciente
El tratamiento de la PDR será más exitoso cuando la relación médico-paciente es fuerte, dicen estos médicos.
“Cada vez que me acerco al tratamiento para la PDR, siento al paciente y le explico con mucho cuidado cuáles son las consecuencias si se presenta”, dice la Dra. Lim. “Desarrollo una relación similar a un trabajo en equipo. Su trabajo es aparecer e informarse sobre los síntomas, y mi trabajo es asegurarme de tratarlo adecuadamente. También recomiendo su aceptación sobre el tratamiento que hacemos, por lo que es una decisión compartida. Entonces, los pacientes sienten que han tenido algo que decir y que no se les ha impuesto nada”.
Gestionar la PDR para los pacientes también puede terminar convirtiendo la salud de un paciente en un sentido positivo, sugiere el Dr. Han. “Con la retinopatía diabética, los pacientes ya han visto a muchos proveedores de atención médica en sus vidas y han escuchado muchas malas noticias. A veces, lo que les despierta es la gravedad de su afección ocular, y se necesita mucho para generar confianza. El tratamiento se basa en confianza. Esta es una enfermedad sistémica, no sólo ocular. Pero usted puede salvar una vida y cambiarle la vida al paciente. Los ojos a menudo son los más valorados y pueden ser la motivación para recuperar el equilibrio de su vida”.
El Dr. Han informa que no hay divulgaciones. El Dr. Hsu es consultor de IvericBio, Gyroscope Therapeu tics y Bausch + Lomb, y recibe apoyo de Genentech/ Roche, IvericBio y Aldeyra Therapeutics. La Dra. Lim es consultora de Alcon, Aldeyra Therapeutics, Allergan, Chengdu Kanghong, Eyenuk, Genentech, IvericBio, No vartis, Regeneron y Santen.
Bibliografía:
1. Fathy C, Patel S, Sternberg P Jr, Kohanim S. Disparities in adherence to screening guidelines for diabetic retinopathy in the United States: A comprehensive review and guide for future directions. Semin Ophthalmol 2016;31:4:364-77.
2. Preliminary report on effects of photocoagulation thera py. The Diabetic Retinopathy Study Research Group. Am J Ophthalmol 1976;81:4:383-96.
3. Preti RC, Ramirez LM, Monteiro ML, Carra MK, Pelayes DE, Takahashi WY. Contrast sensitivity evaluation in high risk proliferative diabetic retinopathy treated with panretinal photocoagulation associated or not with intravitreal beva cizumab injections: A randomised clinical trial. Br J Oph thalmol 2013;97:7:885-9.
4. Photocoagulation treatment of proliferative diabetic reti nopathy: The second report of diabetic retinopathy study findings. Ophthalmology 1978;85:1:82-106.

5. Sivaprasad S, Prevost AT, Vasconcelos JC, Riddell A, Mur phy C, Kelly J, Bainbridge J, Tudor-Edwards R, Hopkins D, Hykin P; CLARITY Study Group. Clinical efficacy of intravitreal aflibercept versus panretinal photocoagulation for best corrected visual acuity in patients with proliferative diabetic retinopathy at 52 weeks (CLARITY): A multicentre, single-blinded, randomised, controlled, phase 2b, non-inferiority trial. Lancet 2017;3:389:10085:2193-2203.
6. Writing Committee for the Diabetic Retinopathy Clinical Research Network, Gross JG, Glassman AR, Jampol LM, Inusah S, Aiello LP, Antoszyk AN, Baker CW, Berger BB, Bressler NM, Browning D, Elman MJ, Ferris FL 3rd, Friedman SM, Marcus DM, Melia M, Stockdale CR, Sun JK, Beck RW. Panretinal photocoagulation vs intravitreous ranibizumab for proliferative diabetic retinopathy: A randomized clinical trial. JAMA 2015;314:20:2137-2146.
7. Obeid A, Gao X, Ali FS, Talcott KE, Aderman CM, Hyman L, Ho AC, Hsu J. Loss to follow-up in patients with proliferative diabetic retinopathy after panretinal photocoagulation or intravitreal anti-VEGF injections. Ophthalmology 2018;125:1386-1392.
8. Zhang W, Geng J, Sang A. Effectiveness of panretinal photocoagulation plus intravitreal anti-vegf treatment against prp alone for diabetic retinopathy: A systematic review with meta-analysis. Front Endocrinol (Lausanne) 2022;29:13:807687.
9. Obeid A, Su D, Patel SN, Uhr JH, Borkar D, Gao X, Fineman MS, Regillo CD, Maguire JI, Garg SJ, Hsu J. Outcomes of eyes lost to follow-up with proliferative diabetic retinopathy that received panretinal photocoagulation versus intravitreal anti-vascular endothelial growth factor. Ophthalmology 2019;126:3:407-413.

12 Edición no° 2. Volumen 116 Review of Ophthalmology México 2023
Review of Ophthalmology





Review of Ophthalmology México 2023 www.visionix.com This document is not contractual. ©kosept©Photos: E.Bienvenu, VisionixFeatures and specifications are subject to change without prior notice. www.visionix.com Una imagen completa desde la córnea hasta la coroides. • Full Range imágenes anteriores de rango completo. • OCTA de alta velocidad y densidad para una mejor resolución y progresión. • Imágenes de retina de rango completo (16 x 6,25 mm). optovue solix
Edición no° 2. Volumen 116
Noticiero ALACCSA-R
Los mejores papers del tercer cuatrimestre del 2022
Este artículo salió en el Noticiero # 56 enero - febrero y se publicó con el permiso de ALACCSA -R. Su reproducción está prohibida. Para más información sobre el noticiero visite la página www.alaccsa.com
Por la Dra. Luisa Anaya, Colombia, y la Dra. Ana S. Serrano, México.
Siempre agradecidas por la oportunidad de trabajar juntas y de ser parte del Noticiero ALACCSA-R. En esta edición de “Lo mejor”, les presentaremos aquellos papers publicados durante el último cuatrimestre del 2022 que nos parecieron más interesantes para conversar y traer cosas nuevas a la mesa para nuestra profesión.
¿Qué hay de nuevo en cirugía de catarata?
Comenzamos con un artículo que demuestra que la posibilidad de operar cataratas con nueva tecnología refractiva, es posible y abre las puertas para que sigamos en la búsqueda de ese lente acomodativo que todos estamos esperando. Les hablo del artículo publicado en Journal of Cataract and Refractive Surgery, en octubre del 2022, por el grupo de Chayet et al1, con un seguimiento por 12 meses a pacientes a quienes se les realizó cirugía para el tratamiento de presbicia y afaquia con lente Juvene (JIOL). Los resultados iniciales son prometedores, se evaluaron 51 ojos de los cuales 16 fueron cirugías bilaterales, encontrando en este grupo mejores resultados. Las agudezas visuales (log MAR) lejanas, intermedias y cercanas corregidas fueron 0,01, 0,08 y 0,24 respectivamente, con una curva de desenfoque entre +1,00 y -2,00 dioptrías. Se trata de un lente modular compuesto por dos piezas (Figura 1): un lente de base monocular (BL), que funciona como el soporte y las hápticas en donde se le inserta un “lente fluídico” (FL) que está compuesto por aceite de silicón y tiene la capacidad de cambiar la curvatura anterior según el estado de acomodación que ejerza la zónula sobre el saco capsular.

Aunque aún se encuentra en investigación, asumen que, este es el mecanismo de acción del lente, y mencionan que los resultados después de 12 meses se mantienen, con mejoría de aspectos muy relevantes como: disfotopsias, sensibilidad al contraste y la ausencia de opacidad de la cápsula anterior y posterior lo cual disminuye la fibrosis del saco capsular y en consecuencia, prolonga la vida útil del efecto aco-

14
Review of Ophthalmology México 2023
Dra. Luisa Anaya
Dra. Ana S. Serrano
modativo de las zónulas. Es importante resaltar que se requiere una buena dilatación (mínimo 6 mm) y el implante del lente se debe hacer minuciosamente, siguiendo todas las recomendaciones para asegurar los resultados. En lo que respecta a la seguridad del lente, se presentó una complicación intraquirúrgica por la no inserción del lente fluídico en una de las 3 pestañas que hacen parte de la base o de las hápticas, 6 pacientes tuvieron inflamación postquirúrgica que requirió prolongación del esquema de corticoides, edema macular cistoide en 4 pacientes, “complicaciones asociadas a diabetes mellitus e hipertensión” en 8 pacientes. Mencionan que 2 pacientes fueron excluidos del estudio por: “severas complicaciones asociadas a la diabetes” y por una membrana epirretiniana no visualizada previa a cirugía por catarata densa.

Los lentes acomodativos con el concepto de “lentes de saco expandido o abierto” sin duda alguna serán muy importantes en nuestro futuro mediato como cirujanos refractivos, ya que representan una solución más acertada fisiológicamente en términos de anatomía y función del segmento anterior.
Otro artículo en tendencia fue el publicado por AlAni et al.2 en el American Journal of Ophthalmology en diciembre 2022, donde exponen los resultados encontrados en una cohorte amplia y retrospectiva de 471 ojos de 372 pacientes con diagnóstico previo de uveítis que fueron operados de catarata entre 2008 y 2020 reportando los hallazgos intraoperatorios y postoperatorios. La mayoría de los pacientes tenían diagnóstico de uveítis anterior (62.3%) y de origen idiopático (25.1%), aunque se incluyeron otras etiologías como HLAB27

Edición no° 2. Volumen 116
Noticiero ALACCSA-R 15

(13.6%), sarcoidosis (9.6%), entre otras. La mediana del tiempo desde el diagnóstico de uveítis hasta la cirugía fue de 3 años (1.4-6.6 años) y la mediana del tiempo de inactividad antes de someterse al procedimiento fue de 1 año (0.5-2 años). Hablando sobre la cirugía de catarata per se, se describe la necesidad de maniobras adicionales como liberación de sinequias posteriores (32.3%) y maniobras para mejorar la dilatación pupilar como ganchos de iris (24%); así mismo, la tasa de complicaciones intraoperatorias reportada de sólo de un 6.8%, reportándose como factor de riesgo por análisis univariado con la presencia de sinequias posteriores y cámara anterior estrecha (<2.5 mm) con p<0.5. Finalmente, reportan una incidencia de complicaciones postoperatorias presentada en la tabla 1, donde lo que más llama la atención es la reactivación de la uveítis (56.5%). Dicha reactivación se presentó dentro de los primeros 6 meses en el 23.8%, dentro del primer año en el 32.5% y dentro del los primeros 2 años en el 41.4% de los casos, sugiriendo y enfatizando la importancia de un seguimiento cercano y a largo plazo en estos pacientes incluso después del periodo de los primeros 6 meses postoperatorios. El tiempo de latencia o inactividad presentó un cociente de riesgo (hazard ratio) de 0.794 con una P=0.003, esto respalda la evidencia de esperar al menos 3 meses de inactividad antes de realizar cirugía de catarata en estos pacientes.
El término “dropless cataract surgery” o cirugía de catarata libre de gotas sigue siendo una idea muy llamativa para aquellos pacientes mayores, con dificultades físicas o con mal apego a tratamiento. Es por esto, que se siguen estudiando diferentes estrategias para evitar o disminuir la dependencia de gotas y así faci-
Review of Ophthalmology México 2023
Tabla 1. Complicaciones postoperatorias presentadas en 471 pacientes con previo diagnóstico de uveítis que fueron operados de cirugía de catarata.
Figura 1. Lente intraocular Juvene - The JIOL, compose of 2 components, a base lens (blue region) and fluid lens (yellow region). When assembled intraoperatively, they form the JIOL device. JIOL = Juvene IOL
Noticiero ALACCSA-R 16
litar el postoperatorio en estos pacientes. El artículo recientemente publicado por el grupo de Lu et al.3 de la Universidad de Pennsylvania en JCRS, nos presenta los resultados de su estudio de casos retrospectivo comparando 262 ojos tratados con acetato de prednisolona 1 mg/1 ml vía tópica y 131 ojos tratados con un implante de dexametasona 0.4 mg insertado intracanalicular (Dextenza®) posterior a cirugía de catarata de rutina con un seguimiento postoperatorio durante 16 semanas. Según lo reportado, ambos grupos tuvieron un comportamiento similar en cuanto a dolor reportado, reacción inflamatoria en cámara anterior, presencia de complicaciones como endoftalmitis y presión intraocular sin diferencias estadísticamente significativas. Se reportó la presencia de rebote inflamatorio en el 6.9% de los pacientes con tratamiento tópico y 9.2% de los pacientes con el implante intracanalicular, con una P=0.5. Además, sólo se reportaron 3 casos de hipertensión ocular (2 y 1 pacientes, respectivamente).
Este artículo nos invita a analizar la posibilidad de este implante como una opción segura y eficaz a analizar una vez disponible en nuestros países y analizando la relación costo/beneficio de nuestra propia población y sistema de salud.
Hablemos sobre ángulos…
Existen opiniones encontradas respecto al peso que tiene el ángulo kappa y alpha en la toma de decisiones dentro del algoritmo de una cirugía refractiva corneal o intraocular y cada vez más contamos con tecnología que nos lleva a un mejor entendimiento de cada uno de los factores que son cruciales para un excelente resultado refractivo.
Salouti et al, publicaron en octubre/2022 en Journal of cataract and Refractive Surgery4 un estudio retrospectivo, observacional, donde analizan cuál es el efecto del ángulo kappa en las mediciones de los mapas de elevación anterior y posterior de dos topó-


grafos: Orbscan y Pentacam. Inicialmente nos recuerdan que tipo de tecnología usa cada uno y por lo tanto cómo obtienen los datos que arrojan: Orbscam es un topógrafo de hendidura con anillos de plácido, por lo cual mide el ángulo que se genera entre el eje pupilar y el centro de reflexión los anillos de plácido sobre la córnea y Pentacam lo hace a través de una cámara Scheimpflug, arrojando datos como: descentramiento del punto más delgado o vértice de la córnea y el eje pupilar, sin dar un dato específico sobre el ángulo kappa. Dicho esto, el objetivo del estudio era demostrar que un ángulo kappa elevado, podría causar un error en la interpretación de las lecturas de los mapas de elevación del Pentacam, que están basados en la esfera de mejor ajuste apical y así clasificar erróneamente una córnea normal como una córnea ectásica.
Un ángulo kappa elevado puede resultar en una ablación descentrada y aún más relevante es la correlación encontrada entre un ángulo kappa elevado y queratometrías más altas en elevación anterior y posterior en los 4 mm centrales en los cuadrantes tem-
Review of Ophthalmology México 2023
Edición no° 2. Volumen 116
Figura 4. Topographic maps of a patient with large angle k and suspected posterior elevation map at the temporal quadrant with otherwise normal topographic features. ACD = anterior chamber depth.
Tabla 2. *Statistical significant - aFront and back keratometric astigmatism tested against front and back elevation, respectively
porales todo esto por el descentramiento en la lectura del estudio en córneas sanas usando la esfera de mejor ajuste. Este efecto se contrarresta si se usa la elipsoide tórica de mejor ajuste, ya que de esta forma se elimina el efecto que tiene el astigmatismo corneal sobre los mapas de elevación.
En conclusión, lo que los autores nos recomiendan es que sí estamos frente a una elevación anterior o posterior (temporales) dudosas, con ángulos kappa elevados y con topografías en su mayoría dentro de parámetros normales, se debe cambiar la esfera de mejor ajuste (BFS) por la elipsoide tórica de mejor ajuste (BFTE) y volver a verificar datos; si después de correlacionar datos, seguimos encontrando alteraciones, se debe hacer un mejor estudio de esa córnea para verificar la viabilidad de un procedimiento quirúrgico como: mapas epiteliales/estromales, histéresis corneal, entre otros.


Si bien es cierto que la medida del ángulo kappa es importante en cirugía refractiva corneal, hoy día se ha vuelto un dato de gran relevancia a la hora de planear una facoemulsificación de catarata, en especial si se colocará un lente premium. Jie Xu et al5 realiza una cohorte prospectiva con 143 ojos y publica en octubre 2022 en el American Journal of Ophthalmology; una serie de variables estadísticamente significativas y determinantes como factores de riesgo para el descentramiento del lente, el cual, cuando supera los 0.4 mm genera cambios importantes en el confort visual.
Este grupo define variables de predicción para descentramiento horizontal y vertical, siendo los más relevantes el White-to-White > a 12 mm y ángulo alpha > 0.50 mm; adicionalmente, ángulos kappa y alpha
Noticiero ALACCSA-R Edición no° 2. Volumen 116
Fixation point Visual axis Pupillary center Corneal center IOL center Center of visual axis Temporal Nasal
Figura 1. Schematic diagram showing the intraocular lens (IOL) decentration, angle a, and angle k.
Noticiero ALACCSA-R 18
elevados horizontal y verticalmente también tienen importancia y favorecen el descentramiento, lo cual se puede explicar por la simetría rotacional del globo ocular, en el cual, el centro de la pupila es cercano al centro del saco capsular. Por el contrario de otros estudios, no se encontró la longitud axial elevada como factor de riesgo, aunque una cámara anterior amplia y un ángulo kappa vertical elevado favorecen el descentramiento vertical.
El beneficio de esta información radica en la interpretación acertada de los estudios que realizamos en el planeamiento de las cirugías refractivas y la identificación de dichos factores de riesgo para la toma de decisiones pre-quirúrgicas óptimas.
Técnicas novedosas en superficie ocular
Siempre es interesante descubrir técnicas nuevas que se realizan a nivel internacional para mejorar el pronóstico y manejo de patologías oculares comunes y no tan comunes que siguen siendo objeto de discusión. Presentaremos 2 de estas técnicas publicadas recientemente en la última edición de International Ophthalmology que nos parecen pueden ser de interés para el público del Noticiero ALACCSA-R.
El primer artículo a presentar es el publicado por Pedrotti y colaboradores, quienes presentan una técnica inspirada en el ya conocido y popularizado SLET (simple limbal epithelial transplantation) desarrollado por el Dr. Sayan Basu hace poco menos de una década. Pedrotti6 describe el SCET (simple conjunctival epithelial transplantation) para cubrir el lecho escleral posterior a excisión de pterigion. Este grupo presenta 6 casos con un seguimiento de 12 meses, donde se realiza vigilancia clínica y con microscopía confocal para valorar la diferenciación de las células implanta-
das con resultados que aparentan prometedores con claras ventajas involucrando mínimo tejido conjuntival donante y aprovechando las propiedades antiinflamatorias y reepitelizantes de la membrana amniótica. La principal diferencia en este procedimiento, además de la toma de tejido conjuntival y no limbal, es que no hay uso de lente de contacto terapéutico, sino que el paciente permanente con el ojo cerrado durante los primeros 2-3 días para aprovechar la nutrición e hidratación de la conjuntiva tarsal. En la figura 2 se pueden observar las imágenes seriadas de la técnica de SCET en este contexto.
Para finalizar pero no menos importante, presentaremos la técnica ALT (allogenic limbal transplantation), una técnica publicada en diciembre de 2022 por Viestenz et al.7 para casos de deficiencia de células del limbo. Esta técnica (figura 3) permite realizar una queratoplastia penetrante y rehabilitar la superficie ocular en un mismo acto quirúrgico con buenos resultados funcionales tomando 1-8 fragmentos de limbo del tejido donante y colocándolos debajo de las suturas (interrumpidas o continuas) entre el tejido receptor y donante. Este grupo de investigadores reporta resultados favorables en 14 casos con deficiencia de células del limbo (5 por quemadura química y 9 por infección) con un seguimiento de 12 meses (figura 4), donde esta técnica permitió acortar el tiempo de rehabilitación visual (a diferencia de realizar las 2 técnicas de manera diferida) con importante mejoría de la agudeza visual, mantenimiento de la transparencia corneal y ausencia de vascularización en el botón donante. El grupo de estudio en su artículo menciona que no queda claro el mecanismo exacto a través del cual las piezas de ALT se integran al tejido, o si las células limbares alogénicas migran hacia el limbo donante o si más bien crean un nuevo limbo. A pesar de lo limitado de la muestra y de que por supuesto amerita mayor estudio y vigilancia, esta técnica resulta prometedora sobre todo para aquellos casos de deficiencia de células del limbo bilateral.

Review of Ophthalmology México 2023
Edición no° 2. Volumen 116
Edición no° 2. Volumen 116
Noticiero ALACCSA-R 19
por técnico quien divide el tejido entre 8-10 fragmentos y los fija con adhesivo tisular a la membrana amniótica criopreservada) se coloca con adhesivo tisular sobre el lecho escleral. E) Se pueden notar los fragmentos de conjuntiva sobre el lecho escleral.
AJUSTE LA VELOCIDAD A SUS NECESIDADES
LA SOLUCIÓN COMPLETA PARA CATARATA Y CÓRNEA

Nuevas funciones:
- Espesor epitelial

- Panel de control de ectasia
- Detección de espolones esclerales
SPECTRALIS con technología SHIFT le permite elegir entre tres velocidades de escaneo OCT para encontrar el equilibrio ideal entre calidad de imagen y rapidez del examen.

ANTERION, con sus nuevas funciones, se convierte en una plataforma verdaderamente completa para el segmento anterior.

200808-001 INT.ES23 © Heidelberg Engineering GmbH SPECTRALIS® ANTERION®
Figura 2. Imágenes intraoperatorias de SCET (simple conjunctival epithelial transplantation): A) Medición del área escleral comprometida por el pterigion. B) Toma de biopsia del tejido conjuntival del área superotemporal. C) Excisión de pterigion y exceso de tenon para dejar lecho escleral desnudo. D) El injerto de SCET (previamente procesado
200811-001 INT.ES23 © Heidelberg Engineering GmbH
A E
C D
B
Noticiero ALACCSA-R
Figura 4. Fotografías clínicas de uno de los casos presentados con antecedente de quemadura química. A) Foto prequirúrgica. B) Postoperatorio a los 2 meses. C) Postoperatorio a los 12 meses. D) Postoperatorio a los 18 meses. La flecha indica un fragmento de ALT.
Bibliografía:
1. Sumit Garg, Melinda T de Jesus, Laura M Fletcher, Arturo Chayet, Enrique Barragán, Patrick Casey; Twelve-month clinical outcomes after implantation of a new, modular, anterior shape-changing fluid optic intraocular lens. J Cataract Refract Surg 2022; 48:1134–1140



2. Al-Ani HH, Sims JL, Niederer RL. Cataract Surgery in Uveitis: Risk Factors, Outcomes, and Complications. Am J Ophthalmol. 2022 Dec;244:117-124

3. Lu, Amy Q. MD, PhD; Rizk, Monica BS; O’Rourke, Tara OD; Goodling, Kristin OD; Lehman, Erik MS; Scott, Ingrid U. MD, MPH; Pantanelli, Seth M. MD, MS. Safety and efficacy of topical vs intracanalicular corticosteroids for the prevention of postoperative inflammation after cataract surgery. Journal of Cataract & Refractive Surgery 48(11):p 1242-1247, November 2022.
4. Ramin Salouti, MD, M. Hossein Nowroozzadeh, MD, Ali Azizi, MD, Kia Salouti, BD, Maryam Ghoreyshi, MD,Reza Oboodi, MD, Zahra Tajbakhsh, MSc; Angle k and its effect on corneal elevation maps in refractive surgery candidates. J Cataract Refract Surg 2022; 48:1148–1154
5. JIE XU A , PEIMIN LIN A , SHAOHUA ZHANG, YI LU, AND TIANYU ZHENG, Risk Factors Associated With Intraocular Lens Decentration After Cataract Surgery, Am JOphthalmol 2022;242: 88–95
6. Pedrotti E, Bertolin M, Fasolo A, Bonacci E, Bosello F, Ponzin D, Marchini G. Autologous simple conjunctival epithelial transplantation for primary pterygium. Int Ophthalmol. 2022 Dec;42(12):3673-3680.
7. Viestenz A, Kesper C, Hammer T, Heinzelmann J, Foja S, Viestenz A. ALT (allogeneic limbal transplantation): a new surgical technique for limbal stem cell deficiency. Int Ophthalmol. 2022 Dec;42(12):3749-3762.

20
Review of Ophthalmology México 2023
Edición no° 2. Volumen 116
Figura 3. Fotografías intraoperatorias de cirugía ALT. A) Finalización de queratoplastia penetrante. B) Preparación de fragmentos de ALT. C y D) Colocación de los fragmentos de ALT debajo de las suturas.
A B C D A B C D

Abordaje de cierre angular agudo
Autores:
Dra. Clemencia De Vivero Arciniegas Médica Oftalmóloga especialista en Glaucoma. Clínica Barraquer. Pontificia Universidad Javeriana. Bogotá, Colombia
Dra.María Camila González Nieto, Médica residente de Oftalmología. Pontificia Universidad Javeriana. Bogotá, Colombia
Correspondencia: cdevivero@javeriana.edu.co
Caso clínico:
Paciente femenina, de 72 años, quien consulta al servicio de urgencias por presentar cuadro clínico que inicia a las tres de la mañana, el cual la despierta súbitamente, consistente en dolor ocular derecho de alta intensidad irradiado a región hemicraneana ipsilateral y acompañado de visión borrosa, enrojecimiento ocular, náuseas y diaforesis. Adicionalmente, presentó dos episodios eméticos y cólico abdominal. Como antecedentes de importancia, la paciente reporta migrañas a repetición, consumo de clonazepam por episodios de ansiedad, antecedente quirúrgico de colecistectomía por colelitiasis, y uso de anteojos por hipermetropía desde la infancia.
Ingresa al servicio de urgencias donde el emergentólogo encuentra paciente álgica, ansiosa, diaforética y con palidez mucocutánea. Signos vitales de ingreso con presión arterial de 90/50 mmHg, frecuencia cardiaca de 140 latidos por minuto y frecuencia respiratoria de 20 respiraciones por minuto. Al examen físico, se encuentra paciente difícil de examinar dada la cefalea intensa que refiere y al palpar el abdomen presenta dolor a la palpación del epigastrio, con dos episodios eméticos posteriormente en el servicio de urgencias. Por lo anterior, realizan impresión diagnóstica de úlcera gástrica y hemorragia subaracnoidea, solicitando endoscopia gástrica y tomografía computarizada de cerebro. Inician manejo con analgésicos y antiespasmódicos sin resolución del cuadro clínico y con exacerbación de la cefalea y franca localización del mismo a nivel del globo ocular derecho.

Se reevalúa la paciente encontrando persistencia de la diaforesis, palidez mucocutánea y marcada fotofobia. A nivel ocular derecho se encuentra córnea opaca, midriasis media de 7 milímetros, reactiva y presión digital alta, con imposibilidad de evaluar estructuras del fondo por opacidad de medios (Figura 1). En ojo izquierdo, se encuentra conjuntiva tranquila, córnea transparente, cámara anterior panda, tonometría digital media, pupila de 3 milímetros reactiva a la luz, cristalino transparente y al fondo de ojo excavación de 0.3, anillo neurorretiniano sano y mácula sana (Figura 2).

22
Review of Ophthalmology
2. Volumen 116 Review of Ophthalmology México 2023
Edición no°
Figura 1. Ojo derecho con opacidad corneal y midriasis media arreactiva.
Se replantea el diagnóstico teniendo en cuenta los hallazgos oculares y se considera un ataque agudo de glaucoma secundario a cierre angular primario en ojo derecho. Se inicia manejo con Manitol al 20% a dosis de 1 gramo por kilogramo de peso, Acetazolamida 250 miligramos vía oral cada 8 horas, Timolol al 0.5% 1 gota cada 12 horas en ojo derecho y Prednisolona al 2% 1 gota tres veces al día. En el ojo izquierdo se indica Isoptocarpina al 2% 1 gota 3 veces al día.
Se remite el caso al oftalmólogo, quien encuentra a la gonioscopia, fuera de los hallazgos descritos, el ángulo de la cámara anterior cerrado en cuatro cuadrantes en ambos ojos y con adecuado control de la presión intraocular con el manejo médico instaurado en urgencias. Realiza iridotomías YAG-láser en ambos ojos (Figura 3).
Comentario:
Se trata de una paciente con una cámara estrecha y un ángulo en cámara anterior cerrado, siendo esto potenciado por su hipermetropía, recordando que son ojos de tamaño pequeño1. Esto es agravado por el uso de Clonazepam que produce midriasis1 y siendo la hora de la presentación del cuadro clínico la madrugada, donde no hay luz, se aumenta la midriasis y se produce el bloqueo del trabéculo, el cual es el sistema de drenaje del humor acuoso. Esto produce un aumento exagerado y súbito de la presión intraocular, siendo este cuadro clínico conocido como ataque agudo de glaucoma por cierre angular.2 El manejo consiste en usar hipotensores del tipo hiperosmótico para disminuir rápidamente la presión intraocular al igual que un hipotensor tópico del tipo betabloqueador si no hay contraindicaciones sistémicas como cuadros de asma bronquial, enfermedad pulmonar obstructiva crónica, bradicardias y bloqueos auriculoventriculares.3
La remisión debe ser prioritaria al oftalmólogo, quien supervisará el manejo tópico y realizará iridotomías con láser, ya que se recomienda su realización inmediatamente después de un cierre agudo tratado con terapia médica.4 En caso de no lograr el control de la presión intraocular, hará una cirugía filtrante tipo trabeculectomía en la mayoría de los pacientes.
Bibliografía:
1. Flores-Sánchez BC, Tatham AJ. Acute angle closure glaucoma. Br J Hosp Med (Lond). 2019 Dec 2;80(12):C174-C179. doi: 10.12968/hmed.2019.80.12.C174. PMID: 31822188.

2. Chan PP, Pang JC, Tham CC. Acute primary angle closure-treatment strategies, evidences and economical considerations. Eye (Lond). 2019 Jan;33(1):110-119. doi: 10.1038/ s41433-018-0278-x. Epub 2018 Nov 22. PMID: 30467424; PMCID: PMC6328531.
3. Kang JM, Tanna AP. Glaucoma. Med Clin North Am. 2021 May;105(3):493-510. doi: 10.1016/j.mcna.2021.01.004. Epub 2021 Apr 2. PMID: 33926643.
4. Sun X, Dai Y, Chen Y, Yu DY, Cringle SJ, Chen J, Kong X, Wang X, Jiang C. Primary angle closure glaucoma: What we know and what we don’t know. Prog Retin Eye Res. 2017 Mar;57:2645. doi: 10.1016/j.preteyeres.2016.12.003. Epub 2016 Dec 28. PMID: 28039061.

2. Volumen
Review of Ophthalmology México 2023
Review of Ophthalmology 23 Edición no°
116
Figura 2. Cámara anterior del ojo izquierdo.
Figura 3. Equipo YAG-láser usado para realización de iridotomías.
Asociaciones y Congresos

Flapectomía como solución al crecimiento intraepitelial por traumatismo en paciente con LASIK previo
Este caso clínico se presentó en el evento FACOELCHE, 25 años, que se llevó a cabo en febrero de 2023.
Autores: Valentina Rodríguez Martini, Julia Alvarez, Rogelio Ribes Escudero, Fernando Mayorga Argañaraz Servicio de Oftalmología del Hospital Alemán
Reporte de caso:
Mujer de 58 años de edad, médica ginecóloga, que concurre a la consulta en nuestro centro, tres meses después de haber sufrido un traumatismo en ojo izquierdo (OI) con un colposcopio, en el ámbito laboral. Presentaba como antecedentes una cirugía de LASIK hipermetrópico cuatro años previos. Al momento del accidente consultó en otro centro donde se le reposicionó el flap epitelial y se le colocó una lente de contacto (LDC). Refiere no haber concurrido a los controles posteriores por el advenimiento del aislamiento por la pandemia COVID-19.
A la exploración oftalmológica presentó agudeza visual mejor corregida (AVMC) de 20/20 en ojo derecho (OD) y 20/30 en OI, presión intraocular en 16 mmHg ambos ojos (AO), motilidad ocular y reflejos pupilares conservados. A la biomicroscopía (BMC) se constató en OI un crecimiento intraepitelial (Imagen 1) y fondo de ojos (FO) AO normal.
Se le realizó una tomografía de coherencia óptica de segmento anterior (OCT SA), donde se visualizan pequeñas áreas de hiperreflectividad compatible con los nidos epiteliales, además, se puede evidenciar zonas de adelgazamiento del flap corneal desde la periferia hacia el centro. A su vez, se observa el sector de amputación del flap por donde se produjo el



24
no° 2. Volumen 116 Review of Ophthalmology México 2023
Edición
Imagen 1. Fotografía de la BMC donde se observa el crecimiento intraepitelial. A, obtenida con corte de luz blanca. B, tomada con luz azul observándose la tinción por pooling por irregularidad en el flap.
Imagen 2. OCT SA OI donde se aprecian los nidos epiteliales hiperreflectivos.
Asociaciones y Congresos

crecimiento intraepitelial. (Imagen 2). La topografía presenta irregularidad en los anillos de plácido en OI concordante con la irregularidad epitelial. Se informa alterado el resultado del índice de dispersión objetiva (“Objective Scatter Index” u OSI) en el HD Analyzer, es un parámetro que brinda información respecto a la dispersión de la luz y a la calidad visual dependiendo de la opacificación de medios y la calidad de la lágrima.
Se llevó a cabo una conducta expectante administrando plasma rico en plaquetas. Luego de 6 meses del traumatismo presentó disminución de su visión en OI con AVMC de 20/50. Con el objetivo de evitar el melting corneal, retirar el crecimiento intraepitelial y mejorar la AV de la paciente, se decidió resolver quirúrgicamente el caso, realizando una flapectomía con desbridamiento y utilizando mitomicina C (MMC) como coadyuvante. Durante el procedimiento, al levantar el flap, se detectó un buttonhole central, motivo por el cual se decidió retirarlo. Luego se realizó pulido del lecho estromal con fresa, seguido por la colocación de MMC y, por último, se colocó una lente de contacto terapéutica (Imagen 3).
La evolución postoperatoria fue favorable con una AVMC de 20/20 en OI, sin evidencia de crecimiento intraepitelial remanente a la BMC (Imagen 4). La paciente refirió mejoría en su calidad visual, reflejada en el HD Analyzer postoperatorio. La OCT SA se evidencia epitelio sano. Actualmente, se encuentra en seguimiento luego de dos años del procedimiento con buena evolución.
Revisión del tema
El crecimiento intraepitelial en pacientes operados de LASIK se produce por el desarrollo de células epiteliales por debajo del flap, es decir, en la interfase epitelio-estroma, y ocurre en el 0 al 20% de los pacientes 1,2. La mayoría de los casos son asintomáticos, no progresan e incluso no requieren tratamiento. Existe un pequeño porcentaje (0.92%) que puede presentar disminución de la AV, astigmatismo, melting del flap, cicatrización, irregularidad de la superficie, sensación de cuerpo extraño y fotosensibilidad 1,2
En la biomicroscopía se pueden observar nidos blanco-grisáceos en la interfase epitelio-estroma más predominantemente cercanos a los bordes del flap, donde puede existir tinción positiva de fluoresceína y, cuando es de larga data, áreas de fibrosis. Es más frecuente en pacientes operados de Lasik de tipo hipermetrópico, en reoperaciones, y principalmente
no° 2. Volumen 116
Edición
Asociaciones y Congresos
dentro del primer mes postquirúrgico ³. Aumenta el riesgo en pacientes con defecto epitelial postquirúrgico, erosiones recurrentes, traumatismo, inflamación, mala adherencia y disrupciones del flap (buttonholes). Generalmente, se produce un crecimiento por implantación intraquirúrgica o migración de las células madre limbares.
Dentro de las posibilidades terapéuticas descritas en la bibliografía se encuentra el lifting del flap y remoción de las células con debridamiento mecánico, en combinación con otras terapias. La queratectomía fototerapéutica (PTK) es útil para remover el crecimiento intraepitelial central, generando además un resultado refractivo positivo, pero no es efectivo para remover las zonas periféricas, pudiendo provocar astigmatismos irregulares 2,3. El alcohol y la MMC evitan recidivas, pero pueden tener efectos tóxicos, dañan los queratinocitos, causando queratitis lamelar difusa y pudiendo generar un flap melting. También pueden utilizarse adhesivos de fibrina o suturar flap, lo cual permitiría un correcto posicionamiento entre el flap y el lecho estromal. Otra opción de tratamiento es la amputación del flap, mencionado principalmente en casos de queratitis infecciosa sobre el mismo 4
Eligiendo el tratamiento indicado para cada caso, los resultados finales de la agudeza visual suelen ser favorables ². Las nuevas tecnologías, como el femtosegundo, permiten que los bordes del flap sean más regulares, disminuyendo la probabilidad de que se genere el crecimiento intraepitelial si comparamos con los realizados con el microqueratomo.
Conclusión
El crecimiento intraepitelial es una complicación postquirúrgica del Lasik poco frecuente, generalmente asintomática en sus comienzos. En los pacientes en los que amenace el eje visual, es de buena práctica instaurar un tratamiento inmediato. Existe un abanico de posibilidades terapéuticas; sin embargo, no se ha establecido ninguna como Gold Standard.



Conociendo las distintas técnicas, debe estudiarse cada caso en particular y adaptarse a las circunstancias para brindarle al paciente la mejor terapia posible. Finalmente, individualizando el tratamiento, suelen lograrse buenos resultados visuales. En nuestra paciente se decidió llevar a cabo la combinación de dos técnicas descritas, por un lado, el debridamiento con colocación de MMC y por el otro la amputación o flapectomía con

2. Volumen 116 Review of Ophthalmology México 2023
26 Edición no°
una excelente evolución postquirúrgica.
Imagen 3. Procedimiento quirúrgico. A, Inicio del levantamiento del flap con la marcación previa. B, línea punteada amarilla señala el buttonhole central al momento de remover el flap C, pulido estromal con fresa.
Imagen 4. Fotografía del OI en la lámpara de hendidura sin alteraciones y con epitelio regular.
Asociaciones y Congresos 27

Bibliografías
1. Wilde, C., Messina, M., & Dua, H. S. (2017). Management of recurrent epithelial ingrowth following laser in situ keratomileusis with mechanical debridement, alcohol, mitomycin-C, and fibrin glue. Journal of Cataract & Refractive Surgery, 43(7), 980-984.

2. Rojas, M. C., Lumba, J. D., & Manche, E. E. (2004). Treatment of Epithelial Ingrowth After Laser In Situ Keratomileusis With Mechanical Debridement and Flap Suturing. Archives of ophthalmology, 122(7), 997-1001.


3. Fagerholm, P., Molander, N., Podskochy, A., & Sundelin, S. (2004). Epithelial ingrowth after LASIK treatment with scraping and phototherapeutic keratectomy. Acta ophthalmologica Scandinavica, 82(6), 707-713.
4. Chhadva, P., Cabot, F., Galor, A., Karp, C. L., & Yoo, S. H. (2016). Long-term outcomes of flap amputation after LASIK. Journal of Refractive Surgery, 32(2), 136-137.
5. Ting, D. S. J., Srinivasan, S., & Danjoux, J. P. (2018). Epithelial ingrowth following laser in situ keratomileusis (LASIK): prevalence, risk factors, management and visual outcomes. BMJ open ophthalmology, 3(1), e000133.
no° 2. Volumen 116
Edición
www.glaucoma-laser-assisted-solutions.com/es Glaucoma Laser Assisted SolutionS Tango® Vitra 810® Optimis Fusion® QUANTEL MEDICAL ELLEX brands of Glass_Review_half_Page.indd 1 31/03/2023 16:59:45
Un universo de oportunidades para desacelerar la progresión de la miopía en México
Esta información sobre miopía y su posible control es el resultado del trabajo conjunto e interdisciplinario de los siguientes profesionales de la visión:
Cárdenas L., Luis Javier. Oftalmólogo. Pérez R., Francisco. Licenciado en Optometría. Velázquez G., Rubén. Licenciado en Optometría. Velázquez S., Berenice. Licenciada en Optometría.
Existe hoy en día, un universo de oportunidades para desacelerar el avance de la miopía en México. Queremos presentar información muy interesante de las investigaciones más recientes sobre la miopía y la tecnología avanzada para controlarla a través de los lentes oftálmicos. Una nueva opción que está disponible en México, hace pocos meses.
Trataremos dos temas clave: el manejo de la miopía infantil con lentes oftálmicos y el lanzamiento de los lentes oftálmicos Essilor Stellest en México.

Para comenzar nuestra promesa de hoy, vamos a responder algunas preguntas frecuentes respecto al tema:
¿Por qué es importante que los profesionales de la visión tomen medidas para abordar y manejar la progresión de la miopía, evitando su avance?
Lic. Opt. Berenice Velázquez Sánchez
Comenzaría diciendo que es nuestra responsabilidad como profesionales del cuidado de la visión, desempeñar un papel de liderazgo en la lucha contra la miopía a través de la innovación de vanguardia y la ciencia pionera. Existe una necesidad urgente de proporcionar soluciones que ayuden a los niños a retrasar la progresión de la miopía y evitar, en la medida de lo posible, que desarrollen una miopía alta. Hoy en día, el manejo de la miopía también representa una gran oportunidad para que los profesionales de la visión brindemos la más alta calidad de atención y tengamos
28
no° 2. Volumen 116 Review of Ophthalmology México 2023
Sección Patrocinada Essilor Luxottica
Edición
Los lentes Essilor® Stellest™ ralentizan la progresión de la miopía en promedio, en un 67 %** en comparación con los lentes monofocales, cuando se usan 12 horas al día.

Lentes Essilor® Stellest™ ralentizan la progresión de la miopía. *Euromonitor International, Eyewear 2023 edición; Compañía Essilor International; Valor de mercado según PVP (precio de venta al público) Essilor® y StellestTM son marcas registradas de Essilor International. **En comparación con los lentes monofocales, cuando se usan 12 horas al día; resultados de ensayo clínico prospectivo, controlado, aleatorizado y con doble enmascaramiento de dos años de duración en 54 niños con miopía que usan lentes StellestTM en comparación con 50 niños con miopía que usan lentes monofocales. Resultados de eficacia basados en 32 niños que afirmaron usar lentes StellestTM al menos 12 horas al día todos los días. Bao J. et al. (2021). Control de la miopía con lentes oftálmicos conlentes asféricos: un ensayo clínico aleatorizado de dos años de duración. Invest. Ophtalmol. Vis. Sci.; 62(B):2888.
Sección Patrocinada Essilor Luxottica
¿Cuándo aparece esta alerta de posible pandemia de miopía infantil?
Lic. Opt. Francisco Pérez Robles
Conocemos los hechos. En 2010, había dos mil millones de miopes. Para 2050, habrá cinco mil millones de miopes. Y casi mil millones de personas altamente miopes. La miopía puede progresar rápidamente en los niños, lo que lleva a una miopía alta. Cuanto más joven se vuelva miope un niño, más rápido progresará la miopía. La miopía alta aumenta el riesgo de patología ocular más adelante en la vida con más de diez veces mayor riesgo de desarrollar problemas de visión. ¡Es hora de actuar juntos!
Como hemos visto, las cifras son muy impresionantes y la prevalencia global de la miopía está aumentando a un ritmo alarmante. Oftalmólogos, optometristas y terapeutas de la visión binocular reconocen que la miopía, y en particular la alta miopía, ya no puede considerarse simplemente como un inconveniente de la visión no corregida. La prestación de servicios integrales de gestión de la miopía requiere una gran cantidad de conocimientos tanto en la investigación como en la práctica. Y tenemos la suerte de que ya en México comencemos a tener mucha experiencia en el manejo de la miopía.
un impacto en la vida de muchos niños pequeños, ahora que tenemos las herramientas para detectar y manejar la miopía de manera proactiva.
Los niños y adolescentes son una comunidad de enfoque mundial, ya que representan el futuro y la progresión de la miopía es el tema clave con respecto a ellos. Como optometristas y oftalmólogos, nuestro panorama profesional se centrará cada vez más en la población joven. Este enfoque no solo responde a un problema de salud pública; es una nueva perspectiva comercial para todos nosotros, hacer las cosas bien en torno al bienestar de los niños. El manejo de la miopía y no solo su corrección significa pensar en su futuro, como adultos productivos con menos posibilidades de desarrollar una alta miopía y, posteriormente, otras condiciones que incluso pueden conducir a la discapacidad.
Pediría a todos mis colegas, que se unan a nosotros en esta importante campaña de salud frente a una nueva pandemia: la miopía. Podemos trabajar en equipo para cambiar el futuro con altas habilidades profesionales y las mejores soluciones ópticas para resultados exitosos a corto y largo plazo. Hoy comenzamos a cambiar el concepto de miopía en México.

Si observamos el panorama mundial de la miopía infantil actual, el 90 % de los niños miopes corregidos usan lentes monofocales, y solo entre el 1 y el 3 % de los niños reciben soluciones recetadas para controlar la miopía.
Esto demuestra que el control de la miopía no está muy extendido y que la aceptación por parte de los expertos en la actualidad es baja.
Dada la creciente prevalencia de la miopía y las complicaciones relacionadas, corregir la miopía simplemente no es suficiente.
Desafortunadamente, los números son enormes en el mundo, pero también aquí en México. Los datos de un estudio piloto de 2017 mostraron que en México hay un 21 % de prevalencia de miopía en niños. Debemos entender la importancia de esos números. Como vemos, estamos ante una nueva pandemia y debemos actuar lo más rápido posible.
Por supuesto, ya sabemos hoy que la prevalencia de la miopía y la miopía alta está aumentando en todo el mundo. Un estudio histórico, de 2015 del Brien Holden Vision Institute, estima que la prevalencia de la miopía aumentará en todo el mundo del 34 % de la población mundial en 2020 a casi el 50 % de la población mundial en 2050. Eso significa que se predice
30 Edición no° 2. Volumen 116 Review of Ophthalmology México 2023
Sección Patrocinada Essilor Luxottica 31
que una de cada dos personas tendrá miopía para el año 2050. Y es probable que la prevalencia de la miopía alta también aumente del 5,2 % en 2020 a casi el 10 % para el año 2050. Estas estimaciones futuras de la miopía sugieren que al menos mil millones de personas pueden tener un mayor riesgo potencial de desarrollar permanente discapacidad visual y ceguera, asociadas a miopía alta.
¿Cuáles son los riesgos que se pueden evitar en el ojo humano miope, para que se deba practicar control de miopía de forma regular y protocolaria en los consultorios de visión en el país?
Dr. Luis Javier Cárdenas Lamas
Ahora habló sobre los riesgos asociados con la miopía y complicaciones más graves. La miopía se asocia con un riesgo de afecciones oculares como glaucoma de ángulo abierto, cataratas subcapsulares, desgarros, desprendimientos de retina y degeneración macular miópica, todo lo cual puede conducir a problemas de visión o ceguera. Al desacelerar la progresión de la miopía, es probable que podamos reducir estos impactos en la visión. Pero esto requiere un cambio de paradigma para los profesionales y requiere un esfuerzo a gran escala.
Hay varias banderas amarillas que se pueden levantar para identificar signos de desarrollo temprano de la miopía. Lo primero que debe hacer es identificar los factores de riesgo, a saber, la genética que representa alrededor del 30% de la miopía y los factores ambientales; en particular, los niños que no juegan al aire libre o que no juegan mucho al aire libre pueden desarrollar una miopía temprana. Los niños que hacen un uso excesivo de la pantalla en distancias cortas ex-
Edición no° 2. Volumen 116
perimentan un estrés visual que puede traducirse en miopía, especialmente porque tendrán uno o más déficits en la visión binocular como un retraso acomodado mayor a una dioptría, insuficiencia de convergencia o una relación AC/A alta.
Estos niños corren un mayor riesgo de desarrollar miopía que otros. También se observa que la longitud del ojo aumenta rápidamente en los meses previos a la miopía y, finalmente, un niño con hipermetropía no leve antes de los 8 años debe ser monitoreado de cerca. En cuanto podamos ver las señales de alerta, si no podemos cambiar la genética, debemos intervenir y aconsejar los mejores hábitos de vida y lectura.
Una vez detectado que un niño es miope, ¿cómo sabemos si hay riesgo de progresión de la miopía?
Lic. Opt. Rubén Velázquez Guerrero
En primer lugar, especifiquemos que consideramos miope a cualquier persona que bajo refracción ciclopléjica cuando la acomodación está relajada presenta una refracción de media dioptría o más. Algunos otros le dirían que cualquier visión miope joven progresará y que, por lo tanto, se deben tomar medidas tan pronto como se note la miopía. Calificaría un poco más el enfoque. Desde hace algunos años, podemos basarnos en tablas de crecimiento un poco como las que tiene el pediatra para juzgar la evolución física del niño.
Así, es fácil asociar un riesgo de miopía y, sobre todo, de miopía alta en cualquier niño cuya edad y longitud axial sean conocidas. Estas curvas existen para niños, niñas y por etnia. En general, cualquier puntuación por encima del percentil 50 desencadena

Review of Ophthalmology México 2023
Sección Patrocinada Essilor Luxottica

una estrategia de control de la miopía. Cuanto mayor sea el riesgo de miopía alta en la edad adulta, más intensamente necesito intervenir con todos los medios posibles. Cuanto más pequeño es el niño, más rápida es la progresión, tengo que intervenir, de nuevo, muy rápidamente. Por lo tanto, es necesario actuar a partir de ese momento. La estrategia de control de la miopía puede comenzar muy temprano y solo se alcanza una meseta cuando la longitud axial ya no se mueve. Con estudios avanzados y el importante uso de pantallas en el mundo escolar, no es raro tener que continuar el tratamiento hasta los 22 años o incluso hasta los 24.
¿Cómo podemos ver en una tabla de factores de riesgo, la necesidad de hacer control de miopía de forma inmediata en un niño?
Lic. Opt. Berenice Velásquez Sánchez
Para determinar si el nivel del niño tiene un riesgo bajo, moderado o alto, hemos tomado puntos como son, edad, historia familiar, tiempo que pasa al aire libre y visión de cerca, así como la fracción o progresión de la miopía durante el último año.
Tomemos el ejemplo de un niño de seis años con dos padres miopes que hoy pasa menos de media hora al aire libre y pasa más de tres horas al día en actividades de visión y con una refracción de -1.25 dioptrías. Este niño tiene un alto factor de riesgo de progresión de la miopía, por lo tanto, en ese caso, se debe recomendar una solución de control de inmediato y seguirlo cada seis meses.
Como se mencionó anteriormente, la miopía aumenta las condiciones oculares en el futuro. De hecho, cada dioptría cuenta porque el beneficio de ralentizar la progresión médica es significativo. Esto es extremadamente importante para garantizar una intervención temprana con el manejo de la miopía, lo que significa que la miopía reducida en una dioptría tiene el potencial de disminuir el riesgo de maculopatía en un 40 %, desprendimiento de retina en un 23 %, glaucoma de ángulo abierto en un 16 % y riesgo de discapacidad visual hasta en un 24%.
¿Es verdad que el punto más crítico de control de la miopía es hacer una muy buena refracción y siempre mantener al paciente con la más completa corrección posible, ni más negativa, ni más positiva?
La iniciativa actual se basa en tres objetivos: el primero es la corrección del error visual; segundo; el control de la progresión de la miopía y la tercera; la comodidad de poder ver en cualquier dirección de la mirada en el campo visual. Obviamente tomando el control profesional del entorno visual, las anomalías de la visión binocular, y el control permanente de la refracción y longitud axial. Todo en uno trabajando juntos. ¡No sólo la tecnología de un lente oftálmico!
Este último punto es muy importante; implica nunca dejar a un niño sin corregir o hipo-corregir; Esa es mi clave trabajando duro en este país con todos mis colegas. Trabajando duro para hablar de excelencia en
32
2. Volumen 116 Review of Ophthalmology México 2023
Edición no°
Lic. Opt. Rubén Velázquez Guerrero.
Sección Patrocinada Essilor Luxottica 33
refracción, especialmente con los niños. Nunca dejes que los niños no sean corregidos, o sean sobre corregidos o hipocorregidos porque también implica malos resultados a largo plazo.
Se dice que la miopía más allá de un defecto refractivo es una enfermedad: ¿Por qué?
Dr. Luis Javier Cárdenas Lamas.
La miopía debe ser considerada hoy en día como un factor de riesgo de patología al igual que el glaucoma, la maculopatía, el desprendimiento de retina, por lo que debemos preocuparnos, no solo desde el punto de vista de la visión, sino más importante desde el punto de vista de mantener una buena salud ocular a lo largo de nuestras vidas. Este es el mensaje que enseñamos a nuestros estudiantes de optometría y residentes de oftalmología y me enorgullece decir que hoy, las principales escuelas de oftalmología y optometría del país inician cursos de control de la miopía con la práctica clínica, y los colegios profesionales, de ambos ramos, también están ofreciendo iniciativas profesionales para profundizar en este campo.
Creo que esto es solo el comienzo. ¡Trabajamos para obtener mejores resultados y una nueva cultura de controladores profesionales para el cuidado de la miopía!
¿Qué aspectos claves de la consulta tradicional estándar deben evaluarse con detenimiento para asegurarnos de hacer control de miopía de forma consciente sin generar mayor alteración del sistema visual?
Lic. Opt. Francisco Pérez Robles
Uno: agudeza visual. Siempre es importante porque es la única referencia de salud que nuestros pacientes conocen sobre el estado ocular y visual. Si tienen buena agudeza visual, ¡están convencidos de que el tratamiento está funcionando!
Dos: Estado del sistema de acomodación. En los niños es más que una necesidad evaluar el estado de su sistema de acomodación con pruebas fáciles y rápidas, como la prueba de Donders o la prueba de Sheard, para verificar el sistema y asegurarse de que la acomodación esté completamente relajada para determinar la refracción correcta.
Tres: Evaluación de la visión binocular. Es un poco menos práctica en nuestros exámenes visuales actuales en ópticas, pero con un simple cover test, y la medición de forias, podemos ayudar al paciente a tener un mejor control de la progresión de la miopía. Esto ayuda mucho. Alertas son importantes detectarlas.
Edición no° 2. Volumen 116
Cuatro: Oftalmoscopia: Punto clave muy importante. La prevención clínicamente significativa hoy en día. La evaluación anual del tejido retiniano y fondo de ojo. Muy recomendado. Si puede hacerlo en el momento del examen, o trabaje con una red de profesionales de la visión y envíele al paciente, lo antes posible, y espere los resultados. ¡Es un deber!
Cinco: Longitud Axial. Hablando de miopía, es muy importante conocer con detalle la miopía que tenemos delante. Es por curvatura, córnea muy curva, o es una miopía axial, por longitud axial larga sobre parámetros normales. Necesitamos tener esos datos para establecer un seguimiento del tratamiento, pero también, si no puedes en el momento, envía al paciente a un servicio de la red de trabajo y espera los resultados. Es solo para hacer el protocolo como lo determina el proceso estándar de control de la miopía.
Ten en cuenta que puedes comenzar a recomendar y trabajar con el proceso de control de la miopía con el mínimo, no siempre todo el proceso podría hacerlo en la primera visita. Pero sea paciente y deje que los padres del paciente miope entiendan el tratamiento a largo plazo y recuérdales que debemos trabajar juntos.
Por último:
¿Cuál es el mejor complemento para que los lentes oftálmicos funcionen mejor en una desaceleración de miopía?
Dr. Luis Javier Cárdenas Lamas
Mi mejor recomendación clínica es un pack de hábitos de higiene visual, que en equipo de profesionales clínicos denominamos MIOPÍA.
• Manejar hábitos saludables
• Iluminación adecuada
• Ojos con acomodación relajada
• Presión y Empuje a las actividades al aire libre
• Intervención permanente para controlar la progresión.
• Asegurar una distancia de trabajo de cerca moderada.
Es muy fácil de seguir y recordar.
Nota: Los lentes oftálmicos Essilor Stellest para tratamiento de control y desaceleración de la miopía, están en el mercado mexicano, distribuidos por la compañía EssilorLuxottica México, únicamente.
Review of Ophthalmology México 2023
Reichert 7CR tonómetro automático Tecnología de respuesta corneal


El Reichert 7CR es un tonómetro de alineación automática, sin contacto, que se utiliza para medir la presión intraocular, mediante la aplicación de uno o varios soplos muy suaves de aire en el ojo.
El proceso patentado de aplanamiento bidireccional que emplea el Reichert 7CR permite al dispositivo cuantificar las propiedades biomecánicas de la córnea y minimizar el impacto de ellas sobre la medición de la PIO.
Esta nueva medición, denominada PIO corneal compensada (PIOcc), ha demostrado resultar menos afectada por las propiedades de la córnea que otros métodos de tonometría.
¿Por qué Reichert 7CR?
• PIOg (PIO correlacionada con Goldmann) y PIOcc (PIO compensada en la córnea) se muestran en la pantalla LCD a color.
• La “puntuación” de la medición indica la fiabilidad de las lecturas.
• Rango de medición 7 - 60 mmHg.
• Pantalla táctil.
• La tecnología exclusiva de Reichert garantiza soplos de aire suaves.
• El sistema de detección de aplanamiento en tiempo real proporciona un soplo de aire personalizado para cada medida.
• Sin mentonera, joystick o controles de elevación.
• Impresora interna y transferencia electrónica de datos a través del puerto USB.

Productos 34 Edición no° 2. Volumen 116 Review of Ophthalmology México 2023

OCULUS marca una nueva era en la cirugía del glaucoma
¡La nueva GONIO ready® de OCULUS es simplemente un invento magnífico! Ahora, al realizar el procedimiento MIGS, los cirujanos pueden conectar la lente gonio al microscopio en lugar de tener que sostenerla con la mano. Esto les permite tener las dos manos libres para la cirugía.

Christian Kirchhübel, CEO de OCULUS, está orgulloso del nuevo producto. “Ser capaz de usar ambas manos durante el procedimiento MIGS les abre nuevas posibilidades a los cirujanos y añade un grado de seguridad, tanto para el cirujano como para el paciente. Nuestra nueva GONIO ready® beneficiará a cualquiera que ya esté usando una lente gonio”.
Con la nueva GONIO ready®, la lente gonio se conecta al microscopio a través de un adaptador “cuello de cisne” flexible, conocido como Sistema Flex. Esto evita cualquier presión adicional contra el ojo del paciente. El Flex System es flexible, lo suficiente como para ser movido durante la MIGS y suficientemente resistente al movimiento para no desplazarse inadvertidamente.

OCULUS GONIO ready® está diseñada para un solo uso, lo que significa que cada operación comienza con una lente perfecta. La lente de calidad OCULUS proporciona una excelente profundidad de campo y, a pesar de su reducido tamaño, un campo de visión extraordinariamente grande. Otro beneficio de la solución de un solo uso es que no se pierde tiempo en la esterilización para garantizar que una lente de calidad esté lista para cada operación.
“El lanzamiento de la nueva GONIO ready® OCULUS Surgical permite, ahora, que los cirujanos de glaucoma y cataratas se beneficien de las experiencias adquiridas anteriormente en la cirugía de retina”, comenta Steffen Adamowicz, director de OCULUS Surgical, sobre el lanzamiento. “Cuando introdujimos el sistema BIOM® hace casi 40 años, revolucionamos las técnicas de visualización de gran angular en la cirugía vitreorretiniana. Ahora, los especialistas en glaucoma pueden esperar las capacidades revolucionarias de la GONIO ready® y cómo hará su trabajo quirúrgico diario más fácil y eficiente”.
Se presentará GONIO ready® al público profesional por primera vez en la APAO, en Malasia, en febrero de 2023; sin embargo, no estará disponible ni aprobada en todos los países para esa fecha.
Más oportunidades para ver la nueva GONIO ready® le están esperando en los próximos congresos oftalmológicos.
Si desea concertar una cita de demostración u obtener más informaciones sobre la nueva GONIO Ready®, comuníquese con la sede alemana de OCULUS Surgical, a través de support@oculussurgical.de o, si se encuentra en el continente americano, contacte el equipo de OCULUS Surgical, Inc. en Port St. Lucie, EE. UU., a través de info@oculussurgical.com, o a su distribuidor local de OCULUS Surgical.
Productos 36 Edición no° 2. Volumen 116 Review of Ophthalmology México 2023

Seguimiento de la progresión del glaucoma: lo aprobado, lo verdadero y lo nuevo
(Este artículo fue traducido, adaptado e impreso con autorización exclusiva del grupo de revistas de Review de Jobson Medical Information. Su reproducción está prohibida).
Por Christine Yue Leonard, editora sénior asociada
Los expertos comparten cómo controlar el glaucoma y discuten la próxima generación de pruebas remotas.
Sin una definición unificada de glaucoma y lo que significa que empeore, el seguimiento de la progresión de la enfermedad es una forma de arte. Aquí, los expertos desglosan los elementos clave del seguimiento del glaucoma con tomografía de coherencia óptica y campos visuales, y discuten el potencial de la realidad virtual y los dispositivos de seguimiento remotos.

Evaluación de la estructura y la función
Figura 1. Ejemplo de artefacto de prueba de campo visual. El paciente no respondió a los estímulos iniciales en los cuatro cuadrantes de prueba preliminares. Después de la instrucción de responder a los estímulos, el paciente posteriormente “respondió en exceso” durante el resto de la prueba, como lo demuestra la alta tasa de falsos positivos. Foto: Ahmad Aref, MD, MBA.
Al examinar a los pacientes en busca de signos de progresión, los expertos observan varios parámetros de OCT, incluido el nervio óptico, el espesor de la capa de fibra nerviosa retiniana peripapilar, los espesores de cuadrante superior e inferior y el espesor del complejo de células ganglionares. Los cambios observados en la OCT se comparan con los hallazgos de la biomicroscopía de lámpara de hendidura directa o los campos visuales, y viceversa.
Se utilizan tres pruebas estructurales principales: el escaneo circular, el escaneo sectorial y el escaneo macular. “Cada una de estas pruebas tiene beneficios para determinados pacientes, por lo que las usamos todas”, dice Steven L. Mansberger, MD, MPH, presidente de oftalmología de Chenoweth y director del servicio de glaucoma en el Devers Eye Institute, en Portland. “La medición del espesor global de la RNFL en el escaneo circular es una combinación de todos los cuadrantes. Lo que constituye un cambio significativo es discutible, pero un cambio de 10 µm generalmente se considera significativo. Sin embargo, si ve un cambio de 6 µm en un paciente que obviamente está progresando, no hay necesidad de esperar hasta que muestre 10 µm de cambio para tomar una decisión.
Oftalmólogo Digital 38 Edición no° 2. Volumen 116 Review of Ophthalmology México 2023
“En la investigación, también utilizamos el ancho mínimo del borde, que es un escaneo sectorial del nervio óptico”, continúa. “Todavía estamos tratando de entender dónde encaja mejor este parámetro en nuestra evaluación de pacientes con glaucoma. Puede ser más útil que el escaneo circular para monitorear a los pacientes que han llegado al piso. El espesor macular es otro parámetro que estamos estudiando. Estamos tratando de entender cómo encaja en el análisis estructural porque se ve afectado por enfermedades de la retina de la mácula. En general, estas pruebas estructurales funcionan mejor en el glaucoma temprano porque muchos pacientes llegan al piso en etapas posteriores de la enfermedad.
Yvonne Ou, MD, profesora de oftalmología en la Facultad de Medicina de la Universidad de California, San Francisco, dice que cuando los pacientes llegan al piso, lo que demuestra un espesor promedio de RNFL inferior a 70 µm (en Optovue RTVue), la OCT ya no puede ser útil. “El efecto piso hace que sea muy difícil seguir a los pacientes estructuralmente”, dice. “Los campos visuales son más útiles para las etapas posteriores del glaucoma. Tenga en cuenta; sin embargo, que a veces los pacientes pueden tener un espesor medio de RNFL inferior a 70 µm, pero habrá un sector o varios que no están en el piso. Estos sectores podrían incluso ser potencialmente normales en comparación con la base de datos normativa. Es posible que usted aún pueda seguir a estos pacientes con OCT solo en esos sectores específicos.
“Por lo general, anualmente obtengo campos visuales para pacientes con glaucoma temprano y leve, y sin cambios en el campo visual, y a veces, cada dos años para un sospechoso de glaucoma del que tengo poca sospecha”, continúa. “El glaucoma de temprano a moderado, a menudo requiere pruebas de campo visual cada seis meses. Para los pacientes con glaucoma de moderado a avanzado, la OCT puede estar en el piso; así que confío más en las pruebas de campo visual, y las hago tres o cuatro veces al año”.
“Cuando los campos visuales se vuelven bastante severos, con una desviación media por debajo de -19 dB, es más útil cambiar a un estímulo de tamaño cinco porque esto aumenta la frecuencia de ver a un nivel en el que el paciente podría detectar esa área, en comparación con un estímulo de tamaño tres”, señala el Dr. Mansberger. “También recomendamos cambiar a un campo visual 10-2 cuando el campo visual de un paciente amenaza su fijación, porque el 10-2 tiene muchas más presentaciones centrales.
“Asegúrese de observar la desviación media en unas pocas citas, al medir la progresión en los campos visuales”, añade. “El límite para tener una pérdida rela-
tivamente rápida, que creemos que afecta la calidad de vida, es de 1 dB de cambio por año, con un cambio correspondiente del 2,5% por año, en el índice del campo visual”.
Michael V. Boland, MD, PhD, profesor asociado de oftalmología en la Facultad de Medicina de Harvard y director del sitio del Massachusetts Eye and Ear, Lexington, señala que uno de los desafíos logísticos del seguimiento del glaucoma es que, a menudo, no es posible realizar pruebas de campo visual más frecuentes. “Necesitamos hacer más pruebas para identificar rápidamente a las personas que están empeorando”, dice. “Se necesitan varias pruebas por año; una o dos no siempre es suficiente, especialmente teniendo en cuenta la variabilidad en la prueba. Nos vemos obstaculizados por problemas de personal, tiempo y espacio en la clínica. Una cosa que mi práctica está haciendo para recopilar más datos de pacientes es hacer que ciertos pacientes vengan con más frecuencia solo para las pruebas de campo visual”.
Los estudios han informado que la pérdida de densidad de vasos, medida en OCT-A, puede ser un parámetro predictivo para detectar la progresión en el glaucoma avanzado; sin embargo, en su mayor parte, los pacientes que usan la OCT-A permanecen en el ámbito de la investigación. “Todavía estamos esperando a que la OCT-A demuestre un valor predictivo más allá de lo que estamos obteniendo con solo mediciones estructurales”, dice el Dr. Boland. “Es un concepto interesante, pero no tenemos evidencia clara de que cualquier cambio en el flujo sanguíneo sea predictivo, si ocurre antes o incluso simultáneamente con la pérdida de tejido nervioso real que ya hemos medido”.
Variabilidad Test-retest
Las pruebas más frecuentes ayudarán a mitigar alguna variabilidad de test-retest, que es otro desafío que enfrenta cada especialista en glaucoma. “Si un paciente tomara la misma prueba exacta dos veces durante una sola cita, habría alguna variación entre las dos debido a un error dentro del propio instrumento o artefactos, como el operador de la prueba y la capacidad de atención o el estado de alerta del paciente”, dice Ahmad A. Aref, MD, MBA, profesor asociado de oftalmología, director médico y vicepresidente de Asuntos Clínicos en el departamento de oftalmología y ciencias visuales de la Facultad de Medicina de la Universidad de Illinois. “Cuanto más frecuentemente hacemos pruebas, más seguros podemos estar de que un defecto determinado puede empeorar”.
Muchos instrumentos de OCT y de campo visual tienen un software del fabricante que tiene en cuenta la variabilidad del test-retest al analizar el cambio. Si
Oftalmólogo Digital 39 Edición no° 2. Volumen 116 Review of Ophthalmology México 2023
la variabilidad del test-retest de un instrumento es de 7 µm, por ejemplo, cualquier cambio en la medición del espesor mayor de 7 µm se consideraría significativo. Los niveles de error de los instrumentos también pueden variar en función del parámetro. Por ejemplo, el Cirrus OCT tiene una variabilidad de 4 a 5 µm del espesor medio de la RNFL, pero una variabilidad de 7 a 8 µm para los cuadrantes de la RNFL.1
Confíe en el software
Al evaluar la progresión de la enfermedad, los expertos dicen que el software de progresión proporcionado por el proveedor es su amigo. Sin embargo, sigue siendo importante revisar los escaneos originales en busca de cosas que pueden haber pasado por alto o cualquier artefacto.
El software Heidelberg Spectralis Glaucoma Module Premium Edition basa su análisis principalmente en los valores del círculo de cálculo RNFL y BMO-MRW. Maestro2 OCT, de Topcon, utiliza el Hood Report, que muestra la RNFL circumpapilar desplazada y un mapa de umbral simulado.
El Dr. Aref explica que el análisis de progresión guiada (Guided Progression Analysis), de Zeiss, compara una prueba actual, ya sea OCT o campo visual, con la(s) prueba(s) más reciente(s) o con la prueba inicial de un paciente. El GPA (su sigla en inglés) incorpora lo que se esperaría para cada lugar de prueba en términos de varianza normal; cualquier cosa fuera de esto desencadena una alerta de posible empeoramiento de la enfermedad. El software de progresión de Zeiss requiere al menos tres pruebas para determinar la progresión “posible” y al menos cuatro pruebas para determinar la progresión “probable”.
“Si un determinado parámetro ha empeorado más allá de lo que uno esperaría de la variabilidad de test-retest, y si ese empeoramiento ocurriera durante dos pruebas consecutivas, diría que eso es progresión, excluyendo cualquier otra posible razón no glaucomatosa para empeorar”, dice.
“Confío en gran medida en el software ofrecido por el proveedor y en el Guided Progression Analysis para los campos visuales”, dice el Dr. Boland. También utilizo un informe combinado como respaldo, un análisis de estructura-función proporcionado para el Cirrus y el analizador de campo Humphrey (Humphrey Field Analyzer), que ofrece un análisis de cambio tanto para el campo visual como para el nervio óptico, juntos en la misma pantalla. Esto es útil para tratar de correlacionar los cambios en el campo visual con los cambios en el nervio óptico. Las herramientas de Zeiss también
nos permiten interactuar con las pruebas, eliminando las que no nos gustan, para que podamos reiniciar el análisis.
La Dra. Ou dice que el software de análisis de tendencias de RTVue rastrea el espesor de la RNFL y GCC; traza seis pruebas en una sola impresión: dos pruebas de referencia y cuatro de seguimiento. “Como usuario, puede seleccionar cuáles son las pruebas de referencia”, dice. Para los pacientes que han sido seguidos durante una década o más, su prueba de referencia puede no ser relevante. Digamos que habían demostrado progresión y, luego, hicimos la cirugía de glaucoma. Reajustaría su línea de base seleccionando dos pruebas que siguieron a la intervención. También se puede hacer con campos visuales. En el software Zeiss Forum, puede establecer las pruebas de referencia y anotar cuándo se produjeron las intervenciones.
Impedimentos de interpretación
Hay muchos artefactos que pueden complicar la interpretación precisa de la OCT y los campos visuales, desde errores de segmentación hasta una cooperación deficiente del paciente. “Si un estudio se ve afectado por un artefacto (Figura 1), no debe dudar en repetirlo”, dice el Dr. Aref. “Las pruebas se pueden repetir tantas veces como sea necesario para obtener un estudio bueno y preciso para el análisis de la progresión”.
Aquí hay algunos artefactos que pueden afectar la calidad de la exploración y los resultados de las pruebas:
• Opacidades de los medios, ojo seco y enfermedad corneal. Cualquiera de estos puede evitar que la luz se enfoque correctamente, lo que resulta en una exploración de OCT de mala calidad. Además, los pacientes con ojo seco pueden requerir colirios antes de tomarse la prueba de campo visual.
• Ptosis palpebral. Los párpados caídos, que se observan con mayor frecuencia en pacientes mayores, pueden dar la apariencia de un defecto visual, ya que el paciente no puede ver los estímulos oscuros.
• Cataratas. Las cataratas pueden afectar tanto la OCT como los campos visuales al obstruir la luz. “En el caso de los campos visuales, el paciente no está viendo los estímulos no debido al glaucoma, sino a las cataratas”, dice el Dr. Aref.
• Fatiga. El artefacto fatiga es común para las pruebas de campo visual. “Los campos visuales dependen
Digital 40 Edición no° 2. Volumen 116 Review of Ophthalmology México 2023
Oftalmólogo
de la respuesta activa del paciente”, señala el Dr. Aref. “Muchos de nuestros pacientes son mayores y la fatiga puede limitar su capacidad para responder a los estímulos, incluso si se ven estímulos”.
• Nervio óptico anormal. Un nervio óptico anormal no es necesariamente glaucoma; es simplemente diferente de la base de datos normativa. “Los nervios ópticos de los pacientes miopes a menudo tienen una forma ligeramente diferente, algo inclinada o alargada”, continúa. Debido a que la OCT compara la prueba con individuos no miopes (normativos), puede sugerir que esta anormalidad es glaucoma. La miopía no es un artefacto, sino un verdadero defecto. La clave es que cuando están relacionados con la miopía, casi siempre no progresan”.
• Adelgazamiento relacionado con la edad. “En un miope leve es posible que usted no espere que haya ningún cambio año tras año; así que, si observa algún adelgazamiento de la RNFL, considere que la edad es un factor de riesgo para el adelgazamiento”, dice la Dra. Ou. “Probablemente haya algún declive relacionado con la edad, especialmente en pacientes mayores”.
• Esquisis. “La esquisis, o separación de las capas de la retina, comúnmente se pasa por alto”, dice el Dr. Mansberger. “Puede ser sutil, y puede ir y venir (Figura 2). Algunos instrumentos no le permiten inspeccionar realmente el escaneo. A veces, tendrán algoritmos de suavizado que dificultan la detección de esquisis”.
• Atrofia peripapilar. “La atrofia peripapilar ocurre alrededor del nervio óptico; usted verá áreas donde el epitelio pigmentario de la retina se adelgaza o falta”, continúa. “Esto creará un artefacto. A veces, las personas pueden no darse cuenta de que el escáner está pasando por un área de atrofia peripapilar, y es por eso por lo que el escaneo se ve tan anormal.
• Errores de fijación. Los errores de fijación son bastante comunes y se producen cuando el dispositivo no centra la imagen en la misma ubicación a lo largo del tiempo. “Parecerá que el tejido se ha vuelto delgado en un área determinada, y eso se debe a que la imagen no se ha centrado adecuadamente”, dice el Dr. Mansberger.

Oftalmólogo Digital 41 Edición no° 2. Volumen 116
Realidad virtual
La prueba de campo visual estándar es clave para diagnosticar y controlar el glaucoma, pero es subjetiva, tarda varios minutos en administrarse y requiere que los pacientes miren fijamente la máquina durante largos períodos. Los expertos dicen que la perimetría de realidad virtual puede mejorar algunos de estos problemas. Estos dispositivos ganaron atención adicional durante la pandemia, cuando la necesidad de herramientas portátiles de monitoreo remoto se hizo más evidente que nunca.

“Estoy muy entusiasmado con la realidad virtual para detectar la pérdida de campo visual”, dice el Dr. Mansberger. “Estos dispositivos son portátiles, no se necesita una habitación especial para usarlos y pueden emplear las mismas tecnologías que están disponibles en máquinas de campo visual más caras. Son ideales para pacientes que tienen problemas de movilidad o para posicionarse en una máquina normal”.
Sin embargo, todavía hay varios obstáculos con los que estos dispositivos deben lidiar antes de que puedan disfrutar de una adopción clínica generalizada. “Hasta ahora, la mayoría de estos dispositivos no tienen grandes datos normativos transversales, por lo que no sabemos qué es normal y qué es anormal”, señala el Dr. Boland. Entonces, si tienen esos datos, muchos aún no tienen datos normativos longitudinales sustanciales, por lo que no podemos decir si alguien está empeorando o no. Eso es clave desde una perspectiva clínica. El concepto de hacer que la prueba sea más fácil de realizarse, y en diferentes entornos, es muy prometedor, pero todavía hay mucho trabajo por hacer antes de que estén listos para la clínica”.
“Otra de las desventajas es que hay muchos algoritmos y diferentes dispositivos que se utilizan”, dice el Dr. Mansberger. “No se puede tomar los resultados de uno y realizar un seguimiento de la progresión, si el paciente cambia repentinamente a un dispositivo diferente. También puede ser un desafío integrar estos dispositivos en su EHR (Electronic Health Records)”.
Hay varios dispositivos de realidad virtual en desarrollo montados en la cabeza, como:
• VisuALL (Olleyes). El perímetro de VisuALL se ha estudiado en Wills Eye Hospital y en la Universidad de Alabama, Birmingham. Los investigadores informaron una confiabilidad test-retest de la desviación media global “excelente” y una adherencia del 100% entre el 76% de los pacientes (n=17) en un pequeño estudio sobre el cumplimiento y la repetibilidad del dispositivo en el hogar.2 En comparación con el Humphrey Field Analyzer (n=102 ojos), el VisuALL tuvo una correlación

42 Edición no° 2. Volumen 116 Review of Ophthalmology México 2023
Oftalmólogo Digital
Figura 2. La esquisis es una fuente de artefactos comúnmente perdida en la OCT. A menudo viene (en el medio) y se va (abajo), y los algoritmos de suavizado de los dispositivos pueden oscurecerlo. Foto: Steven L. Mansberger, MD, MPH
Figura 3. Paciente con los cascos de realidad virtual (arriba a la izquierda). Pruebas de campo visual de un paciente utilizando Vivid Vision Perimetry (parte inferior) y perimetría automatizada estándar (parte superior, a la derecha). Foto: Yvonne Ou, MD.

significativa de la sensibilidad media global (p=0.001) y un alto rendimiento de diagnóstico en pacientes normales y con glaucoma.3
• Vivid Vision Perimeter (Vivid Vision). La Dra. Ou ha probado y validado el Vivid Vision Perimeter (Figura 3). “El poder de todos estos dispositivos de campo visual de realidad virtual está en su portabilidad y coste relativamente bajo”, dice. “Los pacientes pueden recopilar muchos más datos y podemos hacerle más pruebas para superar los problemas de variabilidad. Hemos enviado a los pacientes a casa con los cascos y los hemos entrenado a través de Zoom. Mientras realizábamos nuestro estudio, estábamos limitados de alguna manera por la pandemia, pero pudimos demostrar la viabilidad de la capacitación remota para las pruebas autoadministradas por el paciente.
“Hicimos que los pacientes se hicieran la prueba 10 veces durante un período de 14 días”, continúa. “Encontramos que la aceptabilidad del paciente de tomarse la prueba, así como la variabilidad del test-retest, eran bastante buenas. Esta prueba en particular es única entre algunas de las pruebas de campo visual de realidad virtual porque utiliza una estrategia de prueba diferente que no requiere que los pacientes supriman su reflejo de foveación, como es el caso con la perimetría automatizada estándar. En esta prueba, los pacientes observan el estímulo moviendo la cabeza hacia él. También pueden utilizar un puntero de control remoto. Este enfoque es más fácil e intuitivo para muchos pacientes porque no tienen que suprimir su deseo de mirar los estímulos.
“Tenemos pruebas que son a la vez contraste fijo y contraste mixto”, dice. “Tenemos varios centros que prueban este perímetro, incluida la Universidad de Nueva York. Necesitamos demostrar que el dispositivo puede detectar la estabilidad del paciente y la progresión del campo visual. Estos estudios tomarán tiempo, pero están en marcha”.
• VF3 (Virtual Field). Las pruebas de campo visual utilizando el perímetro VF3 Virtual Field (estrategia BOLT) fueron similares a las de HFA SITA-Standard 242, según un estudio retrospectivo realizado durante la pandemia, por el departamento de oftalmología de la Universidad de Stony Brook.4 Un total de 76 pacientes se sometieron a pruebas de campo visual virtual, a 48 de los cuales se les realizó HFA el último año. Los investigadores informaron que las pruebas virtuales no demostraron diferencias en la proporción de pérdidas de fijación (diferencia media -0,08, p=0,45) o el número de falsos negativos (diferencia media el 2,07%; p=0,05). Además, no encontraron diferencias significativas en la desviación media entre ambos dispositivos (diferencia media 4.11; p=0.45). En comparación con HFA,
VF3 tuvo una desviación de patrón e índice de campo visual más bajos (diferencias medias -0,23 y -2,87, respectivamente; ambos p=0,05). Las pruebas de realidad virtual tardaron una media de 2,4 minutos menos que la del HFA.
• VirtualEye (BioFormatix). VirtualEye realiza el equivalente a un campo visual de 24-2 de umbral completo. Los investigadores informaron en un estudio de prueba de concepto del año 2014 que el dispositivo detectó de manera confiable grandes defectos del campo visual y estuvo de acuerdo con las mediciones del HFA.5 Cuando se comparó con el HFA (grupo VirtualEye n=84; grupo HFA n=79), el tiempo promedio de prueba de los pacientes fue de 10.6 ±3.3 minutos y 9.4 ±2.1 minutos para las pruebas de VirtualEye de agarre manual y visual, en comparación con 6.1 ±1 minuto para las pruebas SITA Standard.
• VF2000 (Micro Medical Devices). Un análisis transversal de 97 pacientes utilizando el rendimiento diagnóstico del VF2000 informó una sensibilidad y especificidad del 100% para la clasificación de pacientes como glaucoma o no glaucoma, pero una alta proporción de clasificación errónea de la gravedad del glaucoma.6 Alrededor del 28% de los casos moderados se clasificaron erróneamente como leves y el 17% se clasificaron erróneamente como graves; el 20% de los casos graves se clasificaron erróneamente como moderados. La concordancia general entre el VF2000 y el HFA fue de 0.63 en general, 0.76 para el glaucoma leve, 0,37 para el glaucoma moderado y 0,7 para el glaucoma grave.
• AVA Advanced Vision Analyzer (Elisar Vision Technology). Los investigadores realizaron un estudio transversal prospectivo de 160 ojos (85 controles, 75 pacientes con glaucoma) para la evaluación funcional; 15 ojos para la variabilidad de test-retest; y 107 ojos para el ensayo de punto ciego (45 normales, 62 ojos con glaucoma).7 Todos los participantes del estudio se sometieron a las pruebas AVA Elisar Standard Algorithm (ESA) y SITA Standard 24-2. La prueba AVA tomó un poco más de tiempo que el HFA, a 7.08 ±1.55 minutos frente a 6.26 ±0.54 minutos (p=0.228). La diferencia de sensibilidad media sectorial fue de -2,2 ±2,3 dB en controles (p<0,001) y -2,6 ±3,5 dB en pacientes con glaucoma (p<0,001). Para la variabilidad de test-retest, los investigadores encontraron que la variabilidad de respuesta disminuyó con un aumento en la sensibilidad y la excentricidad. Informaron la ubicación precisa del punto ciego, la buena correlación de los índices globales de los métodos de prueba y concluyeron que AVA demostró una “equivalencia sustancial” con el HFA SITA-Standard, y puede evaluar con precisión los campos visuales.
44
no° 2. Volumen 116 Review of Ophthalmology México 2023
Oftalmólogo Digital
Edición
La Dra. Ou dice que los campos visuales de realidad virtual necesitarán un estudio riguroso, pero están listos para convertirse en complementos útiles en la clínica. “Una vez que se ha demostrado que podemos detectar, de forma fiable, la estabilidad y la progresión, estos dispositivos encajarán muy bien en el algoritmo de tratamiento. También pueden ser útiles en pacientes que han tenido una intervención importante, como la cirugía de glaucoma, ya que permitirán la recopilación de más datos de referencia nuevos”.
Seguimiento de la PIO durante todo el día
Una imagen incompleta de la presión ocular de un paciente puede complicar las decisiones de tratamiento. “Hemos comenzado a hacer que los pacientes revisen sus presiones en casa”, dice el Dr. Boland. “Podemos pensar que un paciente está empeorando según las pruebas en la clínica, pero sus presiones parecen estar bien. Ahora estamos encontrando a personas que tienen presiones intraoculares que hacen cosas raras fuera del horario de atención de la clínica, por lo que el seguimiento en el hogar ha sido muy útil”.
Los estudios han informado que la PIO diurna y las fluctuaciones de la PIO pueden ser significativamente más altas que las presiones medidas en el consultorio. En un estudio de 100 pacientes, el 66% tuvo mediciones máximas de la PIO fuera de su cita clínica, con fluctuaciones medias diurnas de la PIO de 7.03 ±2.69 mmHg en comparación con 4.31 ±2.6 mmHg en el consultorio (p<0.003).8
Se ha demostrado que el iCare Home detecta de manera confiable los cambios de la PIO relacionados con la terapia en pacientes con glaucoma e hipertensión ocular, con una fuerte correlación con la tonometría de aplanación Goldmann en el consultorio.9 El entrenamiento remoto también ha mostrado tasas de éxito similares a la enseñanza en persona en el mismo dispositivo.10
El Dr. Boland utiliza un servicio con sede en Utah llamado MyEyes.net que configura a los pacientes con monitores de presión en el hogar. Los pacientes pueden alquilar un tonómetro iCare Home2 por $250 por semana o comprarse uno por $2,995. MyEyes coordina toda la entrega y devolución del dispositivo, eliminando una carga sustancial de las clínicas que desean ofrecer el seguimiento de la presión en el hogar.
Contando células:
Aquí hay dos nuevas formas de contar las células de la retina que algún día pueden ayudar a la detección temprana del daño glaucomatoso:
Oftalmólogo
• Cuantificación de la apoptosis celular. La pérdida de células ganglionares retinianas es una indicación de daño glaucomatoso, pero debe producirse una buena cantidad de daño antes de que se detecte en la OCT o los campos visuales. Ahora, hay una nueva técnica para detectar la pérdida temprana de células ganglionares llamada DARC—Detecting Apoptosing Retinal Cells—, que fue desarrollada por la profesora Francesca M. Cordeiro, profesora y presidenta de oftalmología en el Imperial College de Londres.
¿Cómo funciona DARC? La apoptosis temprana de las células retinianas externaliza la fosfatidilserina, un fosfolípido de la membrana celular, para el cual la proteína anexina A5 tiene una alta afinidad. La anexina marcada con fluorescencia se une a la fosfatidilserina externalizada, y esto hace que las células apoptosas sean visibles en la oftalmoscopia láser de barrido confocal. El grupo de la profesora Cordeiro desarrolló un sistema de inteligencia artificial preciso y reproducible para contar estas células in vivo
Un estudio que utiliza una red neuronal convolucional (el 97% de precisión, el 91,1% de sensibilidad, el 97,1% de especificidad) para contar las células en 40 controles y 20 pacientes con glaucoma informó un número significativamente mayor de apoptosis de células ganglionares de la retina en pacientes que más tarde progresaron en la OCT (p=0,0044).11 Además, se está investigando DARC para atrofia geográfica y DMAE. Se está desarrollando una vía de administración de anexina intranasal, que los investigadores dicen que puede ampliar la adopción de la tecnología (en comparación con la vía intravenosa bien tolerada).12 Los ensayos clínicos de Fase II se completaron el año pasado.
• Óptica adaptativa. El emparejamiento de la OCT con óptica adaptativa, una técnica que mejora la capacidad de un sistema óptico para captar detalles finos al reducir las distorsiones del frente de onda entrante, puede ofrecer otro medio para contar las células retinianas in vivo. Al igual que con DARC, un algoritmo de inteligencia artificial está en desarrollo para asumir la carga de contar células. En un estudio que utilizó un algoritmo de deep learning para segmentar y medir el soma de la capa de células ganglionares con imágenes de OCT de óptica adaptativa, los investigadores informaron que los diámetros del soma de los pacientes con glaucoma eran mayores que los de los controles y que había una fuerte correlación lineal entre la densidad de la capa de las células ganglionares locales y el espesor medido. También informaron un aumento en la correlación estructura-función de los pacientes con glaucoma al usar el sistema de IA en comparación con las mediciones de espesor de la OCT.13
Review of Ophthalmology México 2023
Digital 45 Edición no° 2. Volumen 116
Perlas para el éxito
Monitorear el glaucoma e identificar la progresión es un desafío. Estos son algunos consejos a tener en cuenta:
• Las pantallas de progresión no muestran dónde se produce el daño. El software de análisis utiliza parámetros globales como el espesor medio de la RNFL y la desviación media. “No debe confiar demasiado en estas métricas o parámetros porque puede haber cambios localizados”, dice la Dra. Ou. “Digamos que haya un adelgazamiento localizado de la RNFL o la profundización localizada de un escotoma. Esos se perderán si solo confía en las métricas globales”.
• Estar atento a la hemorragia del nervio óptico. “Por mucho que dependamos de la OCT, el instrumento no detectará una hemorragia del nervio óptico”, dice el Dr. Aref. “La hemorragia del nervio óptico es un marcador de progresión, y si se encuentra, puede tener implicaciones significativas sobre cómo se trata a un paciente. Recuerde examinar el nervio óptico y buscar específicamente una hemorragia”.
• No tenga miedo de repetir las pruebas. “Si sospecha que un paciente está empeorando, lo mejor que puede hacer antes de avanzar en la terapia, a menos que sea obvio que está empeorando, es repetir la prueba en un corto período”, dice el Dr. Mansberger.
La Dra. Ou está de acuerdo: “Siempre vuelva a verificar los campos visuales para confirmar el cambio que ve, antes de avanzar en el tratamiento, especialmente las cirugías como la trabeculectomía o las derivaciones tubulares”.
• Confíe en el software de análisis. “Puede confiar en estos sofisticados paquetes de software”, dice el Dr. Aref. “Son más útiles que revisar las pruebas individuales por su cuenta y elaborar criterios de progresión. Simplemente no tenemos la capacidad de tener en cuenta todo lo que hace un algoritmo, especialmente en una clínica de alto volumen”.
• Conozca el piso de su dispositivo. El piso difiere entre los instrumentos de OCT, ya que cada plataforma tiene sus propios algoritmos para calcular el espesor de la RNFL. “Asegúrese de conocer el piso de su dispositivo, así como el deterioro esperado relacionado con la edad de su sistema, lo que se puede encontrar en la literatura”, dice la Dra. Ou.
Los doctores Ou, Aref y Mansberger no tienen revelaciones financieras relacionadas. El Dr. Boland es consultor de Zeiss, Topcon, Janssen Pharmaceuticals y Allergan.
Referencias
1. Budenz DL. OCT progression analyses. AAO Subspecialty Day 2022.
2. Razeghinejad R, Abu SL, Katz LJ, Myers JS, Racette L. Repeatability of home-based visual field testing using a virtual reality perimeter. Virtual Poster Presentation, American Glaucoma Society Meeting 2022 in Nashville, TN.
3. Razeghinejad R, Gonzalez-Garcia A, Myers JS, Katz LJ. Preliminary report on a novel virtual reality perimeter compared with standard automated perimetry. J Glaucoma 2021;30:17-23.
4. Nanti NB and Lenoci J. Comparison of virtual reality visual field testing to Humphrey visual field testing in an academic ophthalmology practice. Invest Ophthalmol Vis Sci 2021;62:8:3486. 2021 ARVO Meeting Abstract.
5. Wroblewski D, Francis BA, Sadun A, et al. Testing of visual field with virtual reality goggles in manual and visual grasp modes. Biomed Res Int 2014;2014;206082.
6. Shetty V, Sankhe P, Haldipurkar SS, et al. Diagnostic performance of the PalmScan VF2000 virtual reality visual field analyzer for identification and classification of glaucoma. J Ophthalmic Vis Res 2022;17:1:33-41.
7. Narang P, Agarwal A, Srinivasan M and Agarwal A. Advanced Vision Analyzer-Virtual Reality Perimeter: Device validation, functional correlation and comparison with Humphrey Field Analzyer. Ophthalmol Sci 2021;1:2:100035. Poster Presentation, 2018 American Academy of Ophthalmology Meeting in Chicago.
8. Arora T, Bali SJ, Arora V, et al. Diurnal versus office-hour intraocular pressure fluctuations in primary adult onset glaucoma. J Optom 2015;8:4:239-243.
9. Scott AT, Kanaster K, Kaizer AM, et al. The utility of iCare HOME tonometry for detection of therapy-related intraocular pressure changes in glaucoma and ocular hypertension. Ophthalmol Glaucoma 2022;5:1:85-93.
10. Barbour-Hastie CC and Tatham AJ. Teaching home tonometry using a remote video link. Eye (Lond.) 2022;1-5.
11. Normando EM, Yap TE, Maddison J, et al. A CNN-aided method to predict glaucoma progression using DARC (Detection of Apoptosing Retinal Cells). Expert Rev Mol Diagn 2020;7:737-748.
12. Cordeiro MF, Hill D, Patel R, eta l. Detecting retinal cell stress and apoptosis with DARC: Progression from lab to clinic. Prog Retin Eye Res 2022;86:100976.
13. Soltanian-Zadeh S, Kurokawa K, Liu Z, et al. Weakly supervised individual ganglion cell segmentation from adaptive optics OCT images for glaucomatous damage assessment. Optica 2021;8:5:642-651.
Oftalmólogo Digital 46 Edición no° 2. Volumen 116 Review of Ophthalmology México 2023

ALCON
/p. 21
MX
Tel. 5579021866
Email: michelle.betanzos@alcon.com
BVI MEDICAL / p. 25 USA
+32 (4) 361.05.49
FXLahaye@bvimedical.com bvimedical.com
DEWIMED S.A.
/p. 35
MEX
Tel.: (55) 56 06 07 77
Fax.: (55) 56 06 05 20 ventas@dewimed.com.mx www.dewimed.com.mx
ESSILOR
/p. 29
MEX
Essilor México S.A. de C.V.
Tel.: (55) 5130 7310
HEIDELBERG ENGINEERING
/p. 19
MX
ARFAMEX
Tel.: +52 55 5135 6646 • 6648
E-mail: sales@arfamex.com
HERMANN OPHTHALMIC INC
/p. 43
MEX
Teléfono: 044 55 4921 5233 direccion@hmophthalmic.com
LABORATORIOS SOPHIA / Portada 4
COL
Tel.: +57 (1) 3778555
SOPHILINEA: 01800121293 www.sophia.com.mx
E-mail: contacto@sophia.com.mx
OCULUS, INC.
/p. 9
GER
Tel.: 49 (0) 641 2005 0
Fax: 49 (0) 641 2005 2 sales@oculus.de www.oculus.de USA
Tel.:
sales@oculususa.com www.oculususa.com
QUANTEL MEDICAL INC.
/p.
contact@quantel-medical.fr www.quantel-medical.com
TOPCON MEDICAL SYSTEMS
/ p. 1
MEX
Comercializadora Lux, S.A. de C.V.
Pino #307 - 3C, Col. Santa María
Insurgentes
06430, México, D.F.
Ph: +52-555-117-2600 Fax: +52-55478450
www.luxcientifico.mx
Grupo Itsaya
Mina 43, Col. Coyoacán Centro, Delegación Coyoacán, 04000, Ciudad de México, México
Ph: +52-55-5119-0458 / 5752-8384
www.grupoitsaya.com
Soluciones Triana
Insurgentes Centro 64, Interior 302ª, Colonia Juárez, Del. Cuauhtémoc, 06600, Ciudad de México, México
Ph: +52 55 5119 9080
www.solucionestriana.com.mx
TRANSITIONS
/p. 5
MEX
Tel.: (55) 5130-7310
www.transitions.com
VISIONIX
/p. 13
MX
Eyeco
Tel.: +52 55 54003777
eyereyes@gmail.com
Edición no° 2. Volumen
Review of Ophthalmology México 2023
Directorio 48
116
1 425 670 9977
670
Fax: 1 425
0742
17,
USA
(1) 888 660 6726
(1) 888 660 6726 Fax: (1) 406 522 2005 / (1) 406 522 2005
27
Tel.:
/


sophialab.com
Antihistamínico de segunda generación(6)
ACCIÓN
RS:254M2021 SSA IV MATERIAL EXCLUSIVO PARA EL PROFESIONAL DE LA SALUD
NUEVO
Besilato de Bepotastina 15mg/ml ACCIÓN RÁPIDA Y SOSTENIDA (4) MAYOR ALIVIO DE LOS SÍNTOMAS ALÉRGICOS MATUTINOS Y NOCTURNOS (6)
DUAL (1) ALTAMENTE SELECTIVO (2) EFICAZ Y SEGURO (1,2,3)